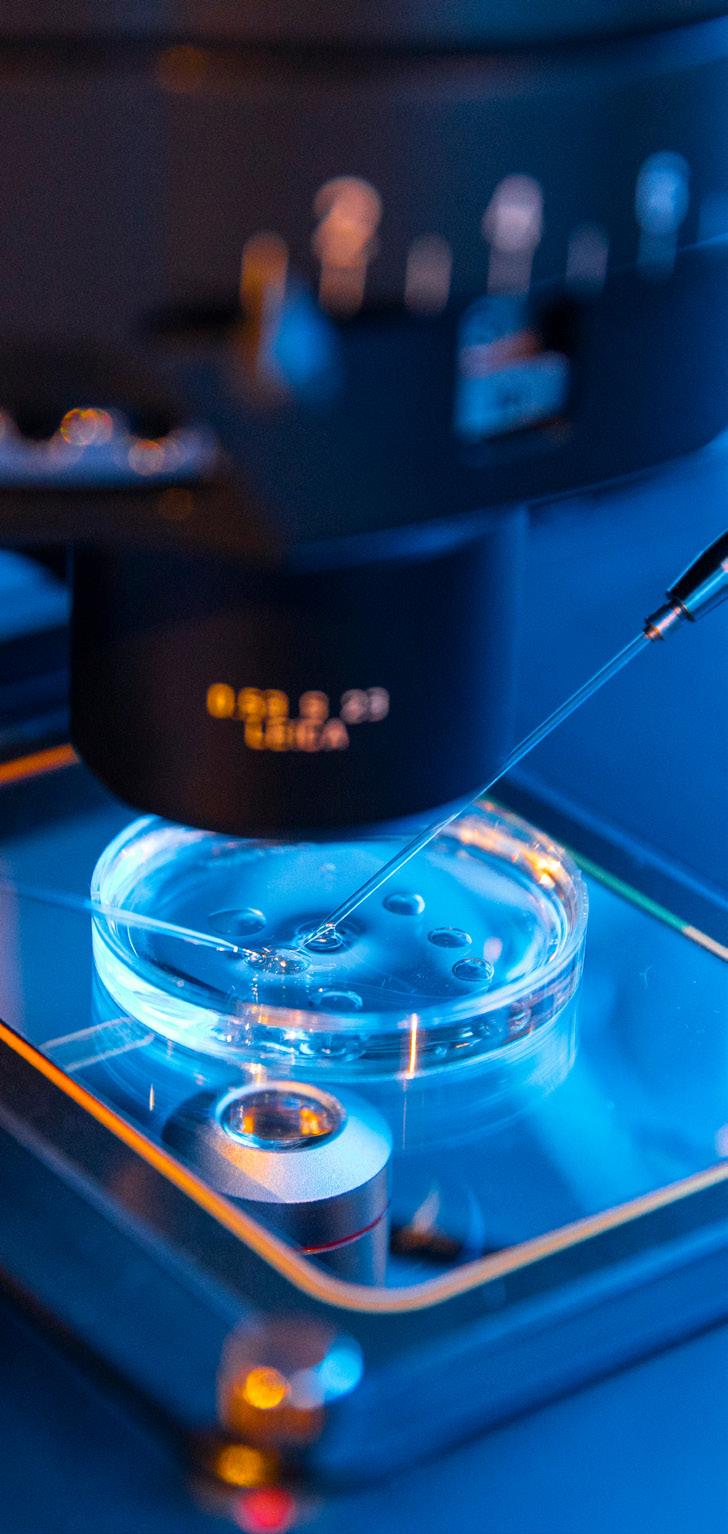

CEO Wissam Younane wissam@bncpublishing.net






CEO Wissam Younane wissam@bncpublishing.net
MANAGING DIRECTOR Rabih Najm rabih@bncpublishing.net
EDITOR IN CHIEF Anil Bhoyrul anil@bncpublishing.net
MANAGING EDITOR Tamara Pupic tamara@bncpublishing.net
FEATURES EDITOR Aalia Mehreen Ahmed aalia@bncpublishing.net
CONTRIBUTING EDITOR Saadiya Ahmad
HEAD OF PARTNERSHIPS Samir Glor Samir@bncpublishing.net
COMMERCIAL LEAD Anna Chipala anna@bncpublishing.net
DIRECTOR OF INNOVATION Sarah Saddouk sarah@bncpublishing.net
GROUP SALES DIRECTOR – B2B GROUP Joaquim D’Costa jo@bncpublishing.net
CREATIVE LEAD Christian Harb chriss@bncpublishing.net
SUBSCRIBE
Contact subscriptions@bncpublishing.net to receive Entrepreneur Middle East every issue
COMMERCIAL ENQUIRIES sales@bncpublishing.net
ENTREPRENEUR.COM
Access fresh content daily on our website




Revolutionising Healthcare in the UAE and the Middle East: Driven by MedTech
Sherif Beshara Group CEO, American Hospital Dubai
Technological Innovations
Propelling the Future of Healthcare in the MENA Region
Healthcare Visionaries
In an era defined by rapid innovation, bold ambitions, and unwavering dedication to improving human health, we are thrilled to present this exclusive edition dedicated to the true pioneers shaping the future of healthcare


Enlighten Your Eternal Beauty, Inside and Out!
@muarjewels www.muarjewels.com
info@muarjewels.com
From telemedicine to robotic surgery, the UAE is reshaping health services with a bold vision and innovation.
When you mention Dubai, people immediately think of incredible skyscrapers, amazing megaprojects, a worldclass airline, and of course, tax-free living. Healthcare is rarely the first thing that springs to mind. Yet, I believe digital healthcare is quietly transforming this country — in ways both profound and personal — and leaders such as Sherif Beshara, Group CEO of American Hospital Dubai (our cover star), are embodying that transformation.
I remember when telemedicine felt futuristic — video calls for a minor ailment or a follow-up were the exception, not the norm. Today, through the Dubai Health Authority’s “Doctor for Every Citizen” initiative — launched in December 2019 — free telehealth consultations (voice or video) are available 24/7. These cover initial consultations and follow-ups with DHAcertified physicians, including electronic prescriptions and requests for lab and radiology tests built in. Originally designed for Emiratis, the service was extended during COVID-19 to all residents of Dubai.
Statistics tell their own story. Between March 2020 and July 2021, more than 241,800 telehealth appointment records were logged under “Doctor for Every Citizen.” Of these, nearly 79 percent of scheduled telehealth visits were completed — a striking sign of both accessibility and patient trust. Meanwhile, through the Dubai Health Authority’s NABIDH platform, more than 1,500 healthcare providers are connected, and over 9.5 million electronic medical records are securely stored, forming the backbone of a unified medical file accessible across the city.
Then there’s robotic surgery. Sheikh Shakhbout Medical City in Abu Dhabi recently announced that since launching its robotic-assisted surgery program in 2020, it has performed 500 such procedures — with more than 200 of them completed in 2024 alone. These are not experimental trials; they represent a mainstream shift toward precision, reduced recovery times, and better patient outcomes. Dubai’s Smart Health Strategy embraces this kind of innovation, emphasizing digital records, AI-driven diagnostics, telehealth, and robotics as pillars of a future-ready system.
For me, what is remarkable is how quickly healthcare here has evolved from being seen as a secondary consideration to becoming a testbed for world-class innovation. A decade ago, most conversations about

Dubai revolved around architecture, aviation, or tourism. Today, increasingly, they include healthcare innovation — and that is no accident. Policy makers, healthcare providers, and private sector leaders have aligned around a shared vision to make digital healthcare not just available, but seamless.
Sherif Beshara and the American Hospital Dubai exemplify this vision. Their investments in advanced technology, patient-centric care, and partnerships with global innovators demonstrate how leadership at the institutional level complements the government’s strategy. It is this blend of bold national planning and private-sector execution that makes the UAE’s healthcare story unique.
Dubai has always prided itself on being ahead of the curve. Now, healthcare is firmly part of that narrative. With initiatives like “Doctor for Every Citizen,” cutting-edge robotic surgery programs, and the Smart Health Strategy, the city is proving that digital transformation is not only about convenience — it is about better health outcomes, for everyone.
Anil Bhoyrul


From embracing innovative MedTech solutions to creating a robust environment for medical advancement, the UAE’s remarkable strides in healthcare has firmly positioned itself as a premier global healthcare destination.
The healthcare sector in the UAE and the wider Middle East is experiencing one of the most profound transformations in its history. Under the visionary leadership of H.H. Sheikh Mohamed bin Zayed Al Nahyan, President of the UAE and Ruler of Abu Dhabi; and H.H. Sheikh Mohammed bin Rashid Al Maktoum, Vice President and Prime Minister of the UAE and Ruler of Dubai, the UAE is now being reshaped by new models of care, digital integration, preventive strategies, and innovation-driven solutions.
In Abu Dhabi, Dubai, and across the UAE, ground-breaking medical innovations are reshaping patient care and establishing new global benchmarks in healthcare excellence. Dubai’s Health Strategy 2030 promotes the creation of smart hospitals and the electronic management of patient records. This ensures secure, rapid access to accurate data, which enhances the quality of care, reduces mistakes, and expedites treatment processes.
Recently, Abu Dhabi’s Department of Health incorporated artificial intelligence (AI) into its clinical workflows. This advanced technology enables healthcare providers

to diagnose chronic conditions such as diabetes and cardiovascular diseases more quickly and precisely by analyzing vast amounts of medical data. By facilitating early detection, these AI-driven solutions allow for prompt treatment, leading to better patient outcomes and more efficient healthcare delivery. This transformation reflects not just the adoption of technology, but a fundamental reimagining of health itself.
THE EVOLUTION OF HEALTHCARE IN THE MIDDLE EAST Healthcare in the Middle East has developed rapidly over the past few decades. Historically, much of the region depended on outbound medical tourism, imported expertise, and external technology. Local systems were primarily reactive, built to address acute illness rather than preventive care or specialized treatments.
The last 20 years, however, have seen an intentional shift toward building world-class facilities and nurturing local expertise. The UAE, for example, has developed advanced hospitals, medical free zones, and research institutions that foster collaboration between clinicians, academics, start-ups, and technology firms. These initiatives have positioned the country as a hub for medical innovation and advanced care.
Digital health has become the backbone of modern healthcare transformation in the Middle East. With high smartphone penetration and a tech-savvy population, the region is well-positioned for the rapid adoption of digital platforms that make care more accessible, efficient, and patient-driven.
Telemedicine has grown from a convenience to a necessity. It provides patients with direct access to healthcare professionals regardless of location, reducing travel, easing pressure on facilities, and connecting underserved populations with vital services. For chronic disease management, remote monitoring solutions feed real-time data from patients to clinicians, enabling timely interventions and preventing emergencies.
Facilitating patient-centric treatment, electronic health records (EHRs) are increasingly used to create seamless continuity of care. When systems are interoperable, they reduce duplication of tests, improve safety, and ensure patients receive consistent treatment across providers. Alongside this, mobile applications now support everything from medication reminders to mental health therapy, putting essential tools in patients’ hands.
Digital platforms not only enhance the efficiency of healthcare delivery but also empower individuals. By giving patients direct access to their health data, test results, and educational resources, they promote active participation in personal well-being.
Innovation is the driving force behind healthcare transformation in the UAE and the wider Middle East. Beyond technological tools, innovation reflects a mindset of continuously improving how care is delivered, financed, and experienced.
The UAE government has invested in start-up ecosystems, research hubs, and accelerator programs that bring together entrepreneurs, investors, and healthcare providers. These ecosystems allow cuttingedge ideas to be tested, refined, and scaled.
Biopharmaceutical research tailored to regional populations are advancing personalized medicine. Digital therapeutics, software-based interventions designed to complement or even replace traditional treatments, are expanding possibilities in areas such as mental health, rehabilitation, and chronic disease management.
New models of care are also taking root, most notably value-based healthcare, which rewards providers for positive patient outcomes rather than the volume of
services delivered. This approach aligns incentives with patient wellbeing, encouraging efficiency, accountability, and long-term results.
Innovation is not just about technology or products, it is about reimagining how care is structured, financed, and measured, ensuring that systems evolve with the changing needs of society.
One of the most significant shifts in regional healthcare is the move from reactive treatment to preventive care. The burden of lifestyle-related conditions such as diabetes, obesity, and cardiovascular disease remain high in the Middle East, demanding solutions that extend beyond clinical treatment.
Preventive care is being integrated into primary health systems, schools, and workplaces. Early screening programs for cancers and chronic conditions are helping detect issues before they escalate. Vaccination drives strengthen community health resilience, while lifestyle campaigns encourage healthier eating, physical activity, and stress management.
Technology enhances these efforts through wearable devices that monitor fitness and heart health, mobile apps that encourage better diet and exercise, and analytics that identify high-risk populations in need of early interventions.
Most importantly, preventive care represents a cultural shift. Health is no longer something to address only when illness strikes, it is a daily priority, shaped by choices, environments, and community support. This holistic approach recognizes that well-being is influenced as much by urban design, education, and lifestyle as by clinical interventions.
Robotic surgery is transforming healthcare across the Middle East, with Dubai standing out as a key center for this medical revolution. By combining advanced robotics with surgical expertise, the region is witnessing a shift toward more precise, minimally invasive, and patientfriendly procedures.
At its core, robotic surgery involves the use of highly advanced systems that translate a surgeon’s hand movements into smaller, more accurate actions inside the body. These systems provide magnified 3D views, eliminate natural hand tremors, and allow access to hardto-reach areas. For patients, this means smaller incisions, less pain, reduced risk of complications, shorter hospital stays, and quicker recovery times.


The Middle East has embraced this technology as part of its push to modernize healthcare and meet rising demand for specialized treatments. Robotic systems are being used across a growing range of specialties, including urology, gynecology, orthopedics, bariatrics, and oncology. Procedures such as prostate surgery, hysterectomy, joint replacement, and even complex tumor removal is now performed with the assistance of robots, offering outcomes that were once difficult to achieve with traditional techniques.
Dubai, in particular, has been quick to integrate robotic medicine into its broader healthcare landscape. The city’s commitment to innovation, combined with its tech-savvy population, makes it an ideal environment for adopting new medical technologies. Patients are increasingly aware of the benefits of robotic-assisted procedures and
are seeking them out as safer, more effective alternatives to conventional surgery.
The adoption of robotic medicine is also addressing an important regional need: reducing medical tourism. In the past, many Middle Eastern patients travelled abroad for complex or high-risk procedures. Today, advanced robotic technologies are available locally, providing the same global standards of care within the region itself. This not only improves convenience for patients but also strengthens local healthcare systems by building expertise and trust.
Beyond surgery, robotics is extending into areas such as rehabilitation and pharmacy. Robotic exoskeletons are being used to support patients in regaining mobility after strokes or spinal injuries, while robotic systems
Continuous professional development programs ensure that doctors, nurses, and allied health professionals stay current with global best practices.

in pharmacies are improving accuracy and efficiency in medication dispensing. Together, these innovations highlight how robotics is not limited to the operating room, but is reshaping the entire patient journey.
Robotic surgery and medicine represent more than just technological progress, they reflect a new era of healthcare built around precision, safety, and patient experience. For Dubai and the wider Middle East, this transformation is not only raising standards of treatment, but also setting the stage for the region to become a global hub for medical innovation.
Amid technological and systemic advances, people remain the foundation of healthcare. Human capital is the sector’s most critical asset, and the Middle East is increasingly focused on developing a workforce capable of meeting future challenges.
Specialized training is being prioritized in fields such as genomics, robotics, and health informatics. Clinicians are expected to blend medical expertise with digital literacy and data science skills, reflecting the interdisciplinary nature of modern healthcare.
Continuous professional development programs ensure that doctors, nurses, and allied health professionals stay current with global best practices. At the same time, initiatives to attract and retain local talent help reduce reliance on external expertise and build long-term sustainability.
Diversity and inclusion are also gaining attention, ensuring that the workforce reflects the multicultural communities it serves. A resilient and adaptable healthcare workforce is not only about numbers but about nurturing expertise, adaptability, and a culture of lifelong learning.
AI has emerged as one of the most transformative forces across various sectors globally, reshaping industries and redefining possibilities.

Despite rapid technological advancements, one principle remains constant: healthcare is fundamentally about people. Patient-centered care has become the cornerstone of transformation, ensuring that systems remain grounded in empathy, dignity, and partnership.
This approach recognizes patients as active participants, not passive recipients. It values their input, involves them in decision-making, and adapts care to individual preferences and cultural sensitivities. In a diverse region like the UAE, where populations include many nationalities and backgrounds, such sensitivity is vital.
Transparency in communication, respect for privacy, and personalized treatment plans strengthen the relationship between patients and providers. Digital tools support this philosophy by offering access to medical information,
real-time feedback mechanisms, and platforms for ongoing engagement.
Ultimately, patient-centered care ensures that amid innovation and transformation, healthcare never loses sight of its human purpose.
Healthcare challenges are rarely confined to national boundaries. Diseases spread globally, research advances through international cooperation, and solutions increasingly require cross-border collaboration. The UAE and Middle East have embraced this reality by fostering partnerships with leading global institutions, universities, and private-sector innovators.
Joint research projects explore areas such as genomics, oncology, and infectious disease control. Academic

affiliations bring world-class training opportunities to local students and professionals. Public-private partnerships create platforms for innovation and scale solutions faster.
By positioning itself as a hub for collaboration, the Middle East not only elevates its own standards of care but also contributes to global progress in medicine and healthcare delivery.
AI has emerged as one of the most transformative forces across various sectors globally, reshaping industries and redefining possibilities. Among its most promising applications is in healthcare and wellness, where AI’s capabilities are revolutionizing disease diagnosis, treatment personalization, patient monitoring, and health management. The UAE, a nation known for its rapid modernization and forward-thinking policies, stands out as a leading example
of integrating AI into its healthcare ecosystem, positioning itself as a regional hub for innovation and advanced medical services. These developments are not only influencing healthcare in the UAE, but are also contributing to a broader global shift towards smarter, more accessible, and more efficient health systems.
AI’s role in healthcare begins with its ability to analyze vast amounts of data rapidly and accurately. Traditional healthcare models often rely on manual interpretation of medical information, which can be time-consuming and prone to human error. AI algorithms, particularly those leveraging machine learning and deep learning, can sift through medical images, electronic health records, genetic data, and real-time patient monitoring information to identify patterns and anomalies that might escape human detection. This technological advancement enables earlier diagnosis of diseases such as cancer, cardiovascular conditions, and neurological disorders, increasing the chances of successful treatment outcomes. Moreover, AI-driven diagnostic tools can support healthcare professionals by providing second opinions, reducing diagnostic errors, and enabling more precise treatment plans.
Personalized medicine, which tailors treatment to the individual characteristics of each patient, has gained significant momentum through AI innovations. By analysing genetic information and individual health data, AI systems can predict how patients will respond to specific drugs or therapies, leading to more targeted and effective interventions. This approach not only improves patient outcomes but also reduces healthcare costs by avoiding ineffective treatments.
The UAE has recognized the strategic importance of AI in transforming its healthcare landscape. The nation has invested heavily in establishing a digital health infrastructure, fostering innovation, and creating regulatory frameworks that encourage the adoption of AI technologies. Dubai’s Health Authority (DHA) and the Abu Dhabi Department of Health have launched initiatives to integrate AI into hospitals, clinics, and health data systems. The Dubai AI Lab, for instance, collaborates with global tech firms and research institutions to develop AI solutions tailored to the region’s unique health challenges. These efforts aim to improve healthcare delivery, increase efficiency, and enhance patient experiences.
On a broader scale, the UAE has positioned itself as a regional leader in AI-driven healthcare by hosting international conferences, establishing research hubs, and fostering public-private partnerships. The nation’s Vision 2021 and subsequent National Artificial Intelligence Strategy aims to embed AI across multiple sectors, including healthcare, to drive sustainable development, economic diversification, and improved quality of life. Such initiatives resonate with global trends where nations are increasingly recognizing AI’s potential to address pressing health challenges, especially in the context of aging populations, rising chronic diseases, and healthcare disparities.
One notable example of AI application in the UAE is the use of robotic process automation (RPA) to streamline administrative tasks within healthcare facilities. This technology reduces the administrative burden on medical staff, allowing them to focus more on patient care. Additionally, AI-powered chatbots are providing 24/7 support to patients, answering queries about symptoms, medication management, and appointment scheduling. The UAE is also exploring the deployment of AI-driven telemedicine platforms, which are especially vital in a country with a dispersed population and vast geographical area.
The impact of AI extends beyond clinical applications to include public health surveillance and pandemic response. During the COVID-19 pandemic, AI played a crucial role in modelling disease spread, optimizing resource allocation, and accelerating vaccine development. Machine learning algorithms analyzed data from various sources to predict outbreaks, enabling authorities to implement targeted interventions and contain the virus more effectively. Such capabilities demonstrate AI’s potential to enhance global health security and preparedness for future crises.
In the wellness domain, AI is increasingly integrated into mental health support, nutrition, fitness, and chronic disease management. Virtual mental health assistants, powered by natural language processing, provide accessible counselling and emotional support, reducing barriers to mental healthcare. AI-driven fitness applications customize workout routines based on individual goals and physiological data, motivating users to stay active. Nutritional apps leverage AI to analyze dietary habits and suggest personalized meal plans, promoting healthier eating behaviors. For individuals managing chronic diseases like diabetes or hypertension, AI-enabled remote monitoring devices facilitate continuous health assessment and timely intervention, improving quality of life.
Despite these advancements, the integration of AI into healthcare and wellness systems raises important ethical, legal, and social considerations. Ensuring algorithmic transparency and avoiding biases embedded in AI models are also critical to prevent disparities in healthcare delivery. Regulatory frameworks in the UAE are evolving to address these concerns, balancing innovation with patient rights and safety.
The future of AI in healthcare and wellness appears promising, with ongoing innovations poised to create more intelligent, accessible, and personalized health systems worldwide. As AI technologies become more sophisticated, their ability to predict health risks, optimize treatments, and support wellness initiatives will continue to expand. The integration of AI into healthcare infrastructure will likely lead to more proactive and preventive health approaches, shifting the focus from treatment to early intervention and health maintenance.
In the UAE, the strategic focus on AI-driven healthcare aligns with the broader vision of building a knowledgebased economy and becoming a global hub for technological innovation. By fostering collaborations between government, academia, and industry, the nation aims to develop indigenous AI solutions tailored to its unique demographic and health challenges. These efforts serve as a model for other nations seeking to leverage AI for social good and economic growth.
The UAE’s proactive approach exemplifies how strategic investments and visionary policies can harness AI’s transformative potential, setting a precedent for other nations to follow. Ultimately, AI’s integration into healthcare and wellness promises a future where health services are more efficient, personalized, and accessible, fostering healthier populations worldwide and contributing to the advancement of global health equity.
As healthcare systems grow more advanced, sustainability has become a defining priority. Beyond the immediate need to deliver care, systems must ensure they can endure financially, socially, and environmentally.
Green hospitals and energy-efficient facilities are reducing environmental footprints. Paperless systems and digital records minimize waste, while sustainable procurement practices promote responsible sourcing. Financially, models such as value-based care and preventive strategies reduce long-term costs while improving outcomes.
Social sustainability is equally important, ensuring that access to healthcare is equitable, inclusive, and adaptable to the needs of diverse populations.
A sustainable system is not one that simply survives, it is one that thrives, continuously improving while securing its future for generations to come.
The transformation of healthcare in the UAE and the Middle East is comprehensive and far-reaching. Digital health platforms are connecting patients with care in new ways. Preventive strategies are shifting the focus from illness to wellness. MedTech is reshaping systems, treatments, and models of care. Human capital is being developed to meet tomorrow’s challenges. Patient-centered philosophies ensure that
healthcare remains grounded in empathy and dignity. Crossborder collaborations strengthen regional and global progress. And sustainability secures the future of these advancements.
What emerges is not just a modernization of healthcare, but a reimagining of its very purpose. Health is being defined not simply as the absence of disease, but as a state of well-being embedded in everyday life, supported by systems that are accessible, inclusive, innovative, and sustainable. In this redefined vision, the UAE and the Middle East are not only transforming their own systems but also contributing to the global evolution of healthcare.


Group CEO, American Hospital Dubai
For Sherif Beshara, Group CEO of American Hospital Dubai, excellence is not an occasional milestone but a daily discipline. Under his leadership, American Hospital Dubai is not only setting benchmarks in patient care but also shaping the future of healthcare in the region and beyond. “The pursuit of excellence should be a daily habit,” Beshara notes. “Once this pursuit becomes part of your core functions, it naturally integrates into your performance.”
With Beshara at the helm, American Hospital Dubai has surpassed the traditional healthcare model. He explains that the hospital functions in line with a futureready, comprehensive approach that shows a thorough understanding of the vital role healthcare must play in building communities, supporting the UAE nation, and helping individuals achieve their health and well-being goals. In essence, American Hospital Dubai adheres to the principle of creating asset synergies to support its commitment to patient-centered care. “Asset synergies involve integrating core assets to operate an efficient and ethical organization: top-quality human resources, knowledge and capabilities, technology integration with infrastructure, investment in innovation, sustainability practices, and service excellence,” Beshara explains.
In a knowledge-driven economy like the UAE, home to one of the GCC’s most competitive education sectors, education is more than an asset; it is a necessity. For Beshara, ensuring continuous learning stands among his core responsibilities at American Hospital Dubai. “We have made a deliberate choice to promote medical knowledge and enhance medical professionalism in the UAE and the region, and aim to support the development of the next generation of healthcare leaders in the country,” he says. To put this belief into practice, the hospital launched its educational arm - American Hospital Academic Institute (AHAI) - to develop talented medical staff in the UAE. It has trained over 500 professionals to date. The Institute is affiliated with leading medical schools in the UAE, including the University of Sharjah, Mohammed Bin Rashid University of Medicine and Health Sciences, and Gulf Medical University, empowering young talent to build a career in the healthcare sector. Beshara adds, “We are also establishing a medical college in central Dubai through a memorandum of understanding with the prestigious Baylor College of Medicine in Houston, Texas, and developing the UAE’s first Doctor of Medicine (MD) program.”
Equally central is Beshara’s drive for innovation. He views it as a crucial force shaping the evolution of healthcare, an outlook that led the hospital, in 2020, to establish the region’s first AI-driven research center in partnership with Cerner. “The UAE aims for high AI literacy, and its 2031 National AI Strategy
includes core research and AI-driven innovations across various sectors. American Hospital Dubai was among the first in the region to acknowledge the importance of practising AIled predictive medicine.”
Plus, in 2021, American Hospital Dubai established the first robotic surgical training hub for the MEA region in partnership with Robotic Surgical Systems (RSS) and the UK-based CMR Surgicals, launching the region’s inaugural robotic surgery training hub and educational academy. “Robotic surgeries are the emerging frontier in medicine,” Beshara says. “We were the first private hospital in the UAE to introduce the da Vinci robotic system and are the region’s first private healthcare facility to receive accreditation from the US-based surgical review corporation (SRC).”
Another vital sector driving the UAE’s healthcare prominence is medical tourism. Medical tourism is another key pillar cementing the UAE’s position as a regional healthcare leader, with the sector projected to grow at a CAGR of 8.7% over the next decade to reach US$2.2 billion by 2033. Aligned with this vision, American Hospital Dubai plays a pivotal role as a committed partner in advancing the nation’s medical tourism ambitions. “We have a proven track record in this field,” Beshara points out. “We maintain medical tourism representative offices in Nigeria and Kenya, and have led the AHD Global Initiative international medical tourism campaign in capitals such as London, Paris, Amsterdam, Frankfurt, Zurich, Milan, and Barcelona, promoting Dubai as a medical tourism destination.”
However, Beshara believes that the UAE’s healthcare leaders carry not only a regional but also a global responsibility. In his view, American Hospital Dubai must not simply follow trends but set them—by continuously accelerating performance improvements that ultimately raise the standard of care for patients everywhere. “Everything depends on purpose,” he explains. “What is the purpose of a healthcare provider? To ensure they deliver effective healthcare that improves people’s lives and empowers them to stay healthy. The more we achieve this goal through continuous improvement of performance, the higher the standards we set for the global healthcare industry.”
“We have made a deliberate choice to promote medical knowledge and enhance medical professionalism in the UAE and the region, and aim to support the development of the next generation of healthcare leaders in the country.
In achieving this goal, American Hospital Dubai follows three core practices - Human expertise for people, Innovation for people, and Performance for people. “We base our growth and progress on these principles,” Beshara says. “Innovation broadens the scope of improved patient care, and technology makes innovation a reality. Human expertise is the glue that binds innovation and technology, that makes the delivery of best outcomes for patients a reality.”
As part of this mandate, the hospital has established Centers of Excellence in key fields, including cancer, heart diseases, orthopedics, diabetes, and robotic surgeries, which all set the standard in complex disease management. Beshara adds, “We also prioritize education and mentoring medical professionals to raise medical standards, thereby contributing to improved patient care.”
In addition, American Hospital Dubai’s American Hospital Care Network (AHCN) provides third-party management services to other healthcare providers and facilities. “We are the first hospital in the Middle East to implement this concept of knowledge sharing and mentoring to promote excellence in healthcare practices,” Beshara says. “This further demonstrates our commitment to expanding the circle of benefits for individuals receiving quality healthcare from highly trained medical professionals.”
Another crucial element in improving global industry standards is forming partnerships or collaborations with the world’s leading healthcare providers and innovators. To that end, Beshara says that American Hospital Dubai is a proud member of the Mayo Clinic Member Network. “Our collaboration enables us to translate medical breakthroughs into better patient care,” he says. “Ultimately, industry standards are set when you draw the roadmap and lead the way.”



“We were the first private hospital in the UAE to introduce the da Vinci robotic system and are the region’s first private healthcare facility to receive accreditation from the US-based surgical review corporation (SRC).

Through his drive to elevate healthcare standards worldwide, Beshara’s leadership at American Hospital Dubai is also reinforcing Dubai’s rise as a global hub for medical excellence. “Over a decade ago, Dubai demonstrated foresight by shaping and implementing policies to transform its healthcare sector into a thriving hub of world-class medical services,” he says. “Offering high-quality medical care as a national priority establishes a legacy of healthcare excellence and encourages growth in medical tourism.”
Beshara reiterates that American Hospital Dubai has consistently contributed to Dubai’s medical tourism objectives through its medical tourism representative offices in Lagos, Nigeria, and Nairobi, Kenya, along with a plan to expand to 30 offices across Europe and Africa. “Endorsed by the Dubai Health Authority (DHA), our overseas offices enable patients to access high-quality medical services and innovative healthcare at American Hospital Dubai,” he says. “The expansion showcases our dedication as partners in the esteemed Dubai Health Experience (DXH) brand, which has enhanced the emirate’s global reputation for medical excellence.”
The hospital’s latest medical tourism project was the AHD Global Initiative, an international media tour that showcased how private healthcare providers can align their mission with the government’s vision to reach national goals. “We launched the AHD Global Initiative as the region’s most innovative international medical tourism drive,” Beshara explains. “The initiative visited major capitals, including London, Paris, Amsterdam,
Frankfurt, Zurich, Milan, and Barcelona, highlighting Dubai’s premium medical facilities and American Hospital Dubai’s state-of-the-art, patient-focused healthcare, which has established it as a regional leader in medical excellence.” The global campaign integrated the people-to-people aspect by involving celebrity influencers to foster a stronger connection through engagement and communication, making the relationship more personal, receptive, and inclusive. It also included lucky draws for 14 followers of the celebrity influencers, giving them a chance to participate and learn about American Hospital Dubai’s support for Dubai’s mission to offer world-class healthcare to all.
Even as he champions continuous improvement, Beshara remains clear-eyed about the obstacles that lie ahead. Asked about the most pressing challenges facing the healthcare sector in the Middle East, and how American Hospital Dubai is addressing them, he points to handling disruptions, managing healthcare expenditure and public health needs, capacity building and healthcare talent retention, and the necessity to invest in research and innovation, which encompasses AI. Beshara adds, “There are also realities such as population growth, increasing rates of chronic illness, and demographic changes that have caused a fundamental shift in how healthcare must function. We are living in an era characterized by technological progress in medicine, including wearables, telemedicine, and personalized medicine, alongside breakthroughs in gene therapies, regenerative medicine, and robotic surgery.”

“Daily operational efficiencies provide the foundation for achieving strategic growth; it’s essential to make the synergy between them a routine practice, but you must also master the balancing act.

In this context, Beshara underscores the importance of governments and policymakers adopting a holistic approach, one that integrates more effective regulatory policies, greater investment in infrastructure, and deeper public-private collaboration to drive sustainable solutions. “For example, in the mental health sector, which has gained prominence after the COVID-19 pandemic, the GCC has 2.6 psychiatrists per 100,000 people, compared to 16 per 1,000,000 in the US, according to an Alpen Capital 2025 report,” he explains. “According to Knight Frank’s ‘Mental Health: The Business Case for Facilities in the Middle East,’ the UAE has 5.3 psychiatrists per 1,000,000. population, compared to 19.2 psychiatrists per 100,000 population in the UK.”
The overall aim - Beshara advises - should be to define strategy, develop cross-sector solutions involving innovators, healthcare entities, scientists, and researchers, build human capabilities through education, training, and upskilling, and implement policies for skill retention. “It is equally important to promote a research culture. Governments must encourage and incentivize research in the public and academic sectors through mutually beneficial strategic alliances,” he adds.
“Collaboration in healthcare functions as a catalyst. The UAE actively partners with many countries to develop inclusive solutions.”

Beshara’s leadership journey was shaped by years in the legal field. He held roles ranging from Legal Counsel to Chairman to Group CEO. His philosophy of harmony aligns purpose, people, and performance.
“Once purpose is clearly defined, it becomes the driving force that inspires people and elevates performance in pursuit of that shared vision,” he says. “While purpose is the starting point, you must deliver results. It’s the finish line, and if you don’t reach it, you’ve lost momentum. Leadership involves sustaining that momentum to achieve the results you desire for your organization.”
For Beshara, results go far beyond financial performance. To him, true success is defined by a fully motivated workforce, efficient processes, demonstrable ethics, benchmark standards of care, and a culture of compassion. These priorities, he argues, are what ultimately foster sustainable profit, making it essential to get them right. It’s within this context that he reflects on the challenge every leader faces: striking a balance between immediate operational demands and long-term strategic growth.
“Although some may believe otherwise, the two concepts are not mutually exclusive; in fact, they are interconnected,” he says. “Daily operational efficiencies provide the foundation for achieving strategic growth; it’s essential to make the synergy between them a routine practice, but you must also master the balancing act.”
He notes that the key lies in knowing when to pivot, staying focused on the long-term goal while remaining flexible, market-aware, and resource-efficient in the approach. At American Hospital Dubai, this mindset translates into resilient decision-making, ensuring the organization can adapt to change without losing sight of its larger vision. ‘For example, we follow the double investment principle: we have partnered with Oracle and Cerner to digitize comprehensively for seamless workflow processes that save time, which we then invest in strategic thinking. It’s a good example of how our employees stay focused on the big picture while achieving daily operational efficiencies,” Beshara explains. “Our Service Excellence Program demonstrates
how we achieve daily operational efficiencies while maintaining our focus on the long-term goal.” The program is grounded in five core values—humility, empathy, advisory, reliability, and teamwork, which allows American Hospital Dubai to develop a culture of accountability that extends far beyond day-to-day performance. “This framework not only ensures the delivery of exceptional care to patients, customers, and stakeholders, but also reinforces the hospital’s long-term commitment to shaping the future of healthcare in Dubai and beyond,” Beshara concludes. “It holds us accountable not only to meet our customers’ expectations every day, but also to fulfill our commitment to our long-term objectives.”
‘TREP
American
“There is a timeless symbiosis in leadership: you only grow as a leader if you develop your team. There is no ‘either or’ here. Instead, it’s a now-or-never situation.
Technology, AI, organizational charts, market trends, geopolitical shifts, and socio-economic disruptors, these will continue to shape-shift. These are the variables, and you must stay on top of them.
However, there are also constants: people skills, intuition, inclusivity, empathy, inspiration, and ethics. These qualities are always present and relevant, and you must possess them. There is no trade-off between variables and constants. Recognizing this truth is the first step to understanding the unique combination of leadership that will work for you and your organization.
Every era in history has its own imperatives. The 21st century presents challenges unique to its era, so leadership must be shaped to address these challenges.”
“Daily operational efficiencies provide the foundation for achieving strategic growth; it’s essential to make the synergy between them a routine practice, but you must also master the balancing act.


The healthcare industry both globally and particularly, in the MENA region, is experiencing a remarkable transformation driven by rapid technological innovations, progressive regional initiatives, and evolving models of health insurance. These elements are collectively shaping a new landscape in the region where patient empowerment, efficiency, and quality of care are prioritized. Also redefining the entire healthcare value chain are emerging technologies such as artificial intelligence, telemedicine, blockchain, and robotics which are enhancing diagnostic and treatment capabilities.
THE UAE AND TRANSFORMATIVE HEALTH TECHNOLOGIES
From blockchain technology to precision medicine, the UAE has emerged as a regional pioneer in adopting key transformative health technologies. The nation’s strategic vision is aligned with its broader aspirations of establishing itself as a global hub for innovation, research, and excellence in healthcare.
The UAE’s leadership recognizes the importance of leveraging technology to improve health outcomes, reduce costs, and enhance the overall quality of life for its citizens and residents. This commitment is articulated through national strategies, public-private partnerships, and dedicated investments in health infrastructure.

The UAE’s Centennial 2071 Plan, launched in 2017, prioritizes healthcare development by enhancing infrastructure, expertise, and services to meet international standards, with particular attention to lifestyle-related diseases. The country has also focused on increasing access to healthcare through digitization and positioning itself as a leading destination for medical tourism.
Additionally, the UAE launched the Artificial Intelligence Strategy 2031, aiming to establish the nation as a global leader in AI. Notable examples include Cleveland Clinic Abu Dhabi’s investment in robotic-assisted surgery, especially in urology and cardiology.
Furthermore, the UAE became the first country in the world to appoint an AI minister and signed an agreement with US software company Care AI in 2023 to further advance its healthcare initiatives.
The UAE is leading in digital health innovation, with initiatives like the Dubai Health Authority’s Smart Health Strategy and the “Doctor for Every Citizen” program promoting the adoption of telehealth, blockchain for data security, and digital health platforms. These efforts are supported by broader government programs such as Smart Dubai, positioning the country as a global leader in technology-driven healthcare.

Recognizing the rising burden of chronic diseases, the UAE is increasingly focusing on preventive and personalized medicine, utilizing AI-driven analytics and genetic testing to enable early detection and tailored treatments. Public health campaigns and wellness initiatives further encourage healthier lifestyles, aiming to combat prevalent issues like obesity and diabetes.
Innovation in medical technologies, such as 3D printing, is gaining momentum, with applications spanning prosthetics, implants, and even organ transplants. Prioritized within the 2030 Industrial Strategy, these advancements aim to reduce
dependence on imports and position the UAE as a leader in regenerative medicine and robotics.
Finally, sustainability remains a central focus, with efforts to develop green hospitals and implement AI-driven resource management and IoT-enabled systems. Facilities like Cleveland Clinic Abu Dhabi have achieved notable reductions in energy consumption, and the Department of Health in Abu Dhabi aims to cut greenhouse gas emissions by 20 percent by 2030. These initiatives reflect the UAE’s commitment to creating

environmentally sustainable, technologically advanced healthcare infrastructure aligned with its broader smart city development goals.
With healthcare spending projected to grow annually, the sector continues to evolve rapidly. Key trends shaping the future of UAE healthcare include the integration of digital health and AI, a shift toward preventive and personalized medicine, expansion of healthcare infrastructure, workforce immigration, innovation through
3D printing and advanced medical technologies, and a strong emphasis on sustainability and smart hospitals.
The UAE’s government agencies, including the Dubai Health Authority (DHA), Abu Dhabi Department of Health (ADDOH), and the Ministry of Health and Prevention (MOHAP), are actively implementing initiatives to digitize health services, foster innovation, and encourage research.
Dubai, in particular, has established itself as a regional hub for health tech innovation. The Dubai Health Innovation Hub serves as an incubator for start-ups, academic institutions, and established healthcare providers, promoting the development of solutions like AI diagnostics, telehealth platforms, and health data analytics. The hub facilitates collaboration, funding, and knowledge exchange, creating an ecosystem that accelerates technological adoption.
Guided by a Patient First philosophy, the organization collaborates with experts across various disciplines to pioneer breakthroughs that shape the future of healthcare. In Abu Dhabi, SEHA, the Abu Dhabi Health Services Company, is spearheading a digital transformation strategy that integrates AI, Internet of Things (IoT), and blockchain technologies into its healthcare services. The goal is to create a seamless, patient-centered experience that enhances operational efficiency and clinical outcomes. SEHA’s initiatives include smart clinics, integrated electronic health records, and remote monitoring programs for chronic disease management.
The UAE’s MOHAP is also making significant strides in deploying nationwide e-health initiatives. These include electronic health records accessible across hospitals and clinics, appointment scheduling systems, and patient portals that empower individuals to manage their health actively. These systems aim to improve data sharing, reduce administrative burdens, and foster a more transparent and efficient healthcare system.
The UAE’s proactive approach presents a compelling model for other nations in the region. Its emphasis on innovation, strategic investments, and collaborative ecosystems positions it well to address future healthcare challenges and capitalize on emerging opportunities in health technology.

According to a report by Deloitte*, the adoption of AI and robotics in the Middle East is rapidly transforming the healthcare sector. AI aimed at societal betterment is being integrated alongside robotics, with the global market expanding from $78 billion in 2021 to an anticipated $320 billion by 2030. In the Middle East and UAE specifically, the annual contribution of AI is projected to grow by 34 percent. The use of robots in healthcare is also gaining momentum, supporting digital health initiatives; the sector is expected to generate approximately $626.10 million in 2024, rising to $811.30 million by 2028, with a compound annual growth rate (CAGR) of 6.69 percent over this period.
*( https://www.deloitte.com/middle-east/en/our-thinking/ mepov-magazine/frontiers/transforming-healthcare-in-themiddle-east.html)
The healthcare system in Saudi Arabia is currently experiencing a profound and dynamic transformation, driven by a confluence of technological innovations, strategic government initiatives, and a rising public demand for accessible, efficient, and high-quality health services. At the heart of this revolution is the Kingdom’s Vision 2030, a comprehensive blueprint that aims to diversify the economy, modernize infrastructure, and elevate the healthcare sector to meet international standards. This vision has positioned digital health as a central pillar for future development, recognizing its potential to revolutionise healthcare delivery and improve overall population health outcomes.
Digital health in Saudi Arabia has become a necessity, especially considering the country’s vast and often challenging geography. Rural and isolated areas can face significant obstacles in accessing specialized medical care,


The healthcare system in Saudi Arabia is currently experiencing a profound and dynamic transformation, driven by a confluence of technological innovations, strategic government initiatives, and a rising public demand for accessible, efficient, and highquality health services.
which has historically led to disparities in health outcomes. To address these issues, the Kingdom has embraced telemedicine as a practical and scalable solution. Telehealth platforms now enable healthcare providers to consult with patients remotely, facilitating timely diagnoses, follow-up care, and health education, without the need for patients to travel long distances. This not only improves access but also alleviates the burden on hospitals and clinics, allowing resources to be better allocated.
In tandem with telemedicine, the proliferation of mobile health applications have empowered Saudi citizens to take greater control of their health. These apps offer a range of services, from managing chronic conditions like diabetes and hypertension to scheduling appointments and receiving medical advice, all from the comfort of their homes. One prominent example is Sehhaty, a comprehensive digital platform that connects patients with healthcare providers, provides health records, and facilitates vaccination and screening program. Such initiatives exemplify how Saudi Arabia is actively embracing digital health to bridge gaps, streamline services, and foster a culture of proactive health management.
Overall, the ongoing digital transformation within Saudi Arabia’s healthcare system reflects the country’s commitment to building a resilient, innovative, and accessible health infrastructure. As technology continues to evolve, the Kingdom is poised to become a regional leader in digital health, setting a benchmark for others to follow and ensuring that future generations will benefit from a healthcare system that is more connected, efficient, and patient-focused.
The region’s strategic location, modern infrastructure, and progressive regulatory environment further support its aspirations to be recognized as a leading global health hub. The goal is not just to provide treatment, but to foster a vibrant ecosystem of wellness, innovation, and medical tourism that spans the entire region.
According to a report by Deloitte*, the Kingdom of Saudi Arabia is actively leveraging technology to revolutionize its healthcare system as part of its Vision 2030 agenda. Since 2021, the government has launched the Health Sector Transformation Program, which aims to deliver comprehensive healthcare services to 88 percent of the population and establish a nationwide digital medical records system for all residents by 2025. The Saudi Ministry of Health has collaborated with various technology firms to introduce artificial intelligence (AI) solutions, such as advanced medical imaging and predictive analytics. Notably, King Faisal Specialist Hospital in Riyadh employs AI for cancer diagnosis and treatment planning, while robotic surgical systems are becoming increasingly prevalent across the country. Saudi Arabia’s National AI Strategy 2031 is further integrating AI tools into multiple sectors, including healthcare, to enhance
service delivery. Supporting this vision, Altib, the Middle East’s largest AI-driven digital health platform, secured $44 million in funding in 2022 to develop fully integrated primary care services, aligning with the goals outlined in Saudi Vision 2030 (as reported by the World Economic Forum).
Beyond Saudi Arabia, other GCC nations such as Qatar, Kuwait, Oman, and Bahrain are also making significant strides in healthcare innovation through AI and robotics. In Kuwait’s Jaber Hospital, AI is being employed in surgical procedures, endoscopy, and cardiac monitoring, with recent advancements, including the use of 3D visualization devices to enhance surgical precision. Bahrain’s commitment to digital health progress is exemplified by the opening of the King Hamad American Mission Hospital, which emphasizes cuttingedge digital medicine and AI technologies. These efforts reflect a broader regional trend of digital transformation across sectors, including sports and technology, further supported by initiatives highlighted in the World Economic Forum’s reports.
Qatar’s healthcare industry is experiencing a remarkable transformation driven by cutting-edge technologies, patient-

Beyond Saudi Arabia, other GCC nations such as Qatar, Kuwait, Oman, and Bahrain are also making significant strides in healthcare innovation through AI and robotics.
focused policies, and strategic financial commitments. As Qatar progresses with its Digital Government Vision 2030 and aims to establish itself as a regional healthcare leader, several emerging trends are propelling this development forward, including the use of artificial intelligence, healthcare reforms, precision medicine, and more.
Sustainability is also a key focus in the ongoing development of healthcare systems across the region. Leaders are actively exploring and implementing innovative strategies to minimize environmental impact, optimize resource utilisation, and promote health education, recognizing that sustainable practices are essential for long-term success. Green hospital initiatives are being adopted, including the use of energy-efficient buildings, eco-friendly materials, and water conservation measures, to reduce carbon footprints and operational costs. Additionally, comprehensive waste management strategies—covering everything from medical waste disposal to recycling programs, are being put into place

to minimize pollution and ensure safe, responsible handling of healthcare by-products.
Beyond environmental sustainability, there is a strong emphasis on fostering health education and community engagement initiatives that promote preventive care and healthy lifestyles, ultimately reducing the burden on healthcare systems and contributing to overall societal well-being. These efforts align with broader sustainability goals, emphasizing the importance of environmentally conscious and socially responsible healthcare development.
Research and innovation centers across the UAE further bolster its position as a leader in health technology. Institutions like Khalifa University and the Dubai Future Foundation are establishing centers dedicated to regenerative medicine, genomics, and AI in healthcare. International collaborations and investment in research projects aim to translate technological advancements into tangible health benefits.

Moreover, regional efforts to develop robust medical research and innovation hubs are deemed vital for fostering self-sufficiency and economic diversification. By investing strategically in local talent, state-of-the-art infrastructure, and cutting-edge research facilities, the Middle East aims to cultivate a thriving knowledge-based economy.
Building strong research communities and innovation ecosystems not only accelerates the development of new treatments and technologies, but also reduces reliance on external markets and suppliers. This approach positions the region as a leader in healthcare innovation, capable of addressing its unique health challenges while contributing to global medical advancements. Through these combined efforts in sustainability and self-reliance, the region is paving the way for a resilient, forward-thinking healthcare landscape that balances progress with environmental responsibility and economic independence.
The region recognizes that sustainable healthcare growth depends on developing skilled professionals. Numerous initiatives are underway to enhance medical education, attract international talent, and retain local expertise. Universities and medical colleges are establishing partnerships with global institutions to ensure that healthcare professionals are trained to the highest standards.
Additionally, ongoing professional development programs and leadership training are playing a crucial role in empowering local clinicians and administrators by equipping them with the latest knowledge, skills, and best practices. These initiatives foster a culture of continuous learning and adaptability, enabling healthcare professionals to stay abreast of evolving technologies, emerging medical research, and innovative care delivery models. By enhancing their leadership capabilities, these programs also encourage proactive problem-solving, strategic thinking, and effective
decision-making, which are essential for driving meaningful innovation within healthcare settings. Ultimately, this focus on professional growth not only elevates individual competence but also translates into improved patient care, higher standards of service, and a more resilient, responsive healthcare system capable of meeting the diverse needs of the community.
Simultaneously, the significance of insurance in this dynamic environment continues to grow. As healthcare advances towards greater sophistication and personalization, insurance models need to evolve accordingly to maintain affordability, broaden access, and support the long-term sustainability of healthcare systems. The incorporation of digital health technologies into insurance services creates new opportunities for proactive prevention, early detection, and innovative treatment options, ultimately fostering a more patientcentric and outcome-focused approach to care.
Furthermore, this integration paves the way for more personalized insurance plans tailored to individual health profiles, encouraging healthier lifestyles and proactive management of chronic conditions. By leveraging data-driven insights, insurers can offer more precise coverage options and incentives that promote better health outcomes. This synergy between digital health and insurance not only enhances the patient experience but also contributes to more efficient and resilient healthcare ecosystems.
Health insurance in the UAE has undergone significant evolution over recent years. From basic coverage to comprehensive plans that include advanced medical procedures, preventive care, and wellness programs, the insurance sector is adapting to the changing landscape of healthcare. Mandatory health insurance laws in cities like Dubai and Abu Dhabi have expanded coverage, ensuring that a larger segment of the population has access to essential health services.



The digitization of insurance processes, such as online claims submission, virtual customer service, and personalized policy management, has improved efficiency and user experience. Insurers are increasingly leveraging data analytics, AI, and machine learning to assess risk more accurately, detect fraud, and develop customized insurance products tailored to individual health profiles.
Digital health solutions, like wearable health devices and mobile apps, are now often integrated into insurance plans. This allows insurers to incentivize healthy behaviors through rewards or discounts, fostering a preventive approach to healthcare. For instance, policyholders who maintain active lifestyles or participate in wellness programs may benefit from reduced premiums, aligning financial incentives with positive health outcomes.
Furthermore, insurance companies play an essential role in supporting innovation by providing coverage for cutting-edge treatments, experimental therapies, and emerging technologies. As personalized medicine and gene therapies become more prevalent, insurers are exploring new risk-sharing models to make these options accessible and affordable. Valuebased insurance models, which tie reimbursement to health outcomes rather than services rendered, are gaining traction as a means to promote efficiency and quality.
Looking ahead, the future of health insurance in the UAE involves greater personalization, driven by big data and AI. Predictive analytics will enable insurers to identify at-
risk populations early, allowing for targeted preventive interventions. The integration of insurance services with health technologies promises a more seamless, patientcenterd experience, fostering healthier populations and more sustainable healthcare systems.
The wellness industry in the Middle East is projected to experience a significant boom by 2026, driven by increasing awareness of holistic health and a growing middle class seeking premium lifestyle experiences. As urbanization accelerates and disposable incomes rise, more consumers are investing in wellness services such as spa treatments, holistic therapies, fitness programs, and personalized health coaching. Countries like the UAE, Saudi Arabia, and Qatar are emerging as regional hubs for wellness tourism, attracting international visitors seeking luxury wellness retreats and medical tourism. The rise of digital health platforms and mobile apps is further democratizing access to wellness resources, allowing individuals to monitor their health, access virtual consultations, and participate in wellness programs from the comfort of their homes.
The healthcare landscape in the UAE is on the cusp of a revolutionary transformation facilitated by technological innovation, regional strategic initiatives, and adaptive insurance models. The adoption of artificial intelligence, telemedicine, blockchain, robotics, and personalized medicine is creating a more efficient, accessible, and patient-centric

healthcare system. The UAE’s proactive approach, supported by significant investments and forward-thinking policies, positions it as a regional leader and a model for others to emulate.
By embracing innovation and strategic planning, the UAE is set to become a model for delivering efficient, accessible, and personalized healthcare, ultimately improving health outcomes, and setting new standards for the region. As we approach 2026, the Middle East continues its remarkable journey toward establishing itself as a premier global hub for health, wellness, and medical innovation. Empowered by visionary leaders, strategic investments, and a relentless pursuit of excellence, the region is shaping a dynamic healthcare ecosystem that seamlessly integrates cuttingedge technology, world-class infrastructure, and holistic wellness services.
Looking ahead, the future of health insurance in the UAE involves greater personalization, driven by big data and AI. Predictive analytics will enable insurers to identify at-risk populations early, allowing for targeted preventive interventions.




In an era defined by rapid innovation, bold ambitions, and unwavering dedication to improving human health, we are thrilled to present this exclusive edition dedicated to the true pioneers shaping the future of healthcare. Welcome to a celebration of visionaries; leaders, entrepreneurs, and changemakers, whose relentless pursuit of excellence is transforming the Middle East into a global hub for medical innovation, wellness, and compassionate care.
As we move toward 2026, the region is experiencing a remarkable renaissance in healthcare. From cutting-edge


medical technologies and ground-breaking research to luxurious wellness retreats and holistic health solutions, the Middle East is carving out its rightful place on the world stage. Dubai, in particular, has emerged as a shining beacon of this progress, exemplifying a dynamic blend of innovation, luxury, and strategic vision.
This special edition is more than just a showcase of accomplishments; it is a tribute to the individuals whose passion, ingenuity, and leadership are rewriting the story of healthcare in the region. These visionaries are not only



This special edition is more than just a showcase of accomplishments; it is a tribute to the individuals whose passion, ingenuity, and leadership are rewriting the story of healthcare in the region.






elevating standards but are also inspiring a new generation of healthcare professionals and entrepreneurs to dream bigger, push boundaries, and pursue excellence.
Inside these pages, you will discover inspiring profiles, groundbreaking initiatives, and bold strategies that are shaping the future of medicine and wellness. You will learn about the powerful collaborations, technological advancements, and sustainable practices that are transforming healthcare delivery into a seamless, patient-centric experience. Whether you are a seasoned healthcare professional, a budding innovator, or
simply someone passionate about the future of well-being, this edition offers insights, inspiration, and a glimpse into the extraordinary journey that the Middle East is undertaking, one that promises to redefine what it means to care for and heal our communities.
Join us as we celebrate the trailblazers who are turning vision into reality and be inspired by the transformative power of innovation and leadership. Welcome to our special edition for healthcare visionaries; a tribute to those shaping a healthier, more connected, and more compassionate world.


With a proven track record and an extensive portfolio, as the UAE’s new Minister of Health and Prevention, H.E. Ahmed Al Sayegh is set to enhance healthcare services, contribute to the country’s ongoing economic diversification initiatives, and bolster international collaborations.
Reinforcing the UAE’s ongoing commitment to elevating its healthcare sector, on September 1, 2025, His Highness Sheikh Mohammed bin Rashid Al Maktoum, Vice President, Prime Minister, and Ruler of Dubai announced the appointment of H.E. Ahmed Al Sayegh as the new Minister of Health and Prevention. The reshuffle received formal approval from H.H. Sheikh Mohamed bin Zayed Al Nahyan, President of the UAE and Ruler of Abu Dhabi, confirming a unified leadership approach toward fostering global partnerships, and integrating innovative policies to meet future challenges.
Backed by extensive experience in economic development, diplomacy, and public-private sector collaboration, H.E. Al Sayegh initiated his successful career in the energy sector, climbing through the ranks of Abu Dhabi National Oil Company (ADNOC), one of the world’s leading energy companies, prior to helming Dolphin Energy. There, he successfully managed the well-known cross-border ‘Dolphin Gas Project’, a large-scale initiative connecting the UAE, Oman, and Qatar, delivering up to 2 billion cubic feet of natural gas daily. The complex role required navigating international regulations, coordinating with multiple governments, as well as ensuring seamless operations across three countries. Moreover, he also served as a board member of the Abu Dhabi Fund for Development (ADFD), which finances development projects worldwide, as well as Vice Chairman of Emirates Nature–WWF, reflecting his resolute commitment to environmental sustainability as well as green initiatives.
Holding the position of Minister of State at the Ministry of Foreign Affairs since September 2018, H.E. Al Sayegh has been pivotal to the UAE’s economic success. Responsible for driving the country’s economic and trade portfolios, his tenure
was marked by a core focus on diversifying the economy away from oil dependency. He was also instrumental in bolstering bilateral relations with key regions, particularly in Asia and the Commonwealth of Independent States (CIS), as well as attracting international investors and promoting the nation as a global hub for business and commerce.
Moreover, having helped deepen strategic partnerships and foster international cooperation, H.E. Al Sayegh’s role involved working closely with government agencies and private sector stakeholders to promote economic growth, attract foreign investment, and enhance regional diplomacy. His diplomatic expertise and strategic vision have been instrumental in positioning the UAE on the world map as a global hub for commerce and innovation.
In addition, H.E. Al Sayegh has actively contributed to fostering international business relationships. He served as Co-Chair of the UAE-UK Business Council, helping to strengthen trade and investment ties between the two nations. His leadership extended to the private sector, where he held senior roles at Abu Dhabi Global Market (ADGM), Aldar Properties, Masdar, Etihad Airways Group, Mubadala Investment Company, as well as First Gulf Bank. These roles not only highlight his strategic leadership acumen, but also showcase his versatility across sectors, including finance, real estate, renewable energy, and aviation.
His diverse portfolio demonstrates a deep understanding of economic, diplomatic, and strategic issues, attributes that will be vital as he assumes responsibility for the UAE’s healthcare system. H.E. Al Sayegh’s educational background further complements his professional expertise; he holds a bachelor’s degree in Economics from Lewis & Clark College, USA. His academic foundation has provided him with insights into market dynamics, policy formulation, and strategic planning; all skills essential for leading the country’s health initiatives.
The UAE’s leadership recognizes healthcare as a critical pillar of national resilience and social development. Under H.E. Al Sayegh’s stewardship,

H.E. Ahmed Al Sayegh is set to enhance healthcare services, contribute to the country’s ongoing economic diversification initiatives, and bolster international collaborations.
the Ministry of Health and Prevention is expected to implement innovative policies aimed at improving healthcare access, leveraging cuttingedge technologies, and fostering international collaborations. These efforts are aligned with the UAE’s vision to develop a robust, sustainable healthcare system capable of responding to global health challenges, pandemics, and demographic shifts.
H.E. Al Sayegh reflects the UAE’s commitment to strengthening its healthcare system while fostering economic and diplomatic growth. His extensive experience and strategic vision are expected to play a vital role in advancing the nation’s health infrastructure, making it better prepared for future challenges and aligning with the country’s long-term development goals.
According to the official website of the UAE’s Ministry of Health and Prevention, their key objectives for 2023 to 2026 include key objectives; firstly, to plan and manage policies, legislation, research and economics of the health sector based on qualified and reliable big data. Secondly, manage preventive and community healthcare programs to enhance the quality of healthy life at the country level. And third, to regulate the healthcare sector through licensing, monitoring, and inspecting companies, individuals, and medical products.
Under Saudi Arabia’s Vision 2030, H.E. Fahad Abdulrahman AlJalajel is leading efforts to transform healthcare in the Kingdom through innovation and strategic reforms.
Appointed as Minister of Health in the Kingdom on October 15, 2021, H.E. AlJalajel was tasked with leading the Ministry’s development strategies, an effort that significantly accelerated the achievement of its goals. Previously, he served as Deputy Minister of Health for Planning and Development, overseeing the formulation and implementation of the health sector’s transformation strategy. During his tenure, key achievements were made across various areas of healthcare, particularly in digital health development.
H.E. AlJalajel’s participation in supervising emergency response plans to the Covid-19 pandemic and vaccine centers had a significant impact on the Kingdom in not only achieving first levels in the G20, but also achieving the second rank in the pandemic response index. The Kingdom was recognized as a beacon of success in confronting the pandemic, while highly prioritizing the protection of the health of its citizens, residents, and visitors.
Beyond his key role as the Minister of Health, H.E. AlJalajel is also a member of the Council of Economic and Development Affairs, and Chairman of the Transformation Program Committee in the health sector. He is also the Saudi Health Council President, Chairman of the Board of Trustees of the Saudi Commission for Health Specialties, and Chairman of the Board of Directors of the General Authority for Food and Drug.
Playing a key role in the Kingdom’s health sector, H.E. AlJalajel has participated in numerous ministerial councils and national bodies dedicated to community health, prevention, and early disease detection.
He served as a Member of the Council of Ministers and the Council of Economic Affairs and Development, and has chaired many key institutions and committees, including the Saudi Health Council; Food and Drug General Authority; Saudi Red Crescent Authority; Board of Trustees of the Saudi Commission for Health Specialties; Public Health Authority (Weqaya); Health Insurance Council; Health Holding Company; NUPCO (National Company for Unified Procurement
of Medicines, Devices and Medical Supplies); Medical Cities and Specialized Hospitals; Saudi National Institute for Health Research; Saudi Center for Patient Safety; and the Saudi Center for Accreditation of Health Institutions (CBAHI). He also led national and ministerial committees on pandemic preparedness, health-sector cybersecurity, privatisation, tobacco control, traffic safety and health-in-all-policies.
Currently overseeing the transformation plan in the health sector, H.E. AlJalajel has managed many important files during his career in several prominent locations, the most important of which are the General Authority for Investment (currently the Ministry of Investment), Ministry of Commerce and Industry, and Ministry of Health. Educated in the Kingdom, H.E. AlJalajel earned a bachelor’s degree in Computer Science from King Saud University in Riyadh. He went on to complete a master’s degree in Computer Science at St. Joseph’s University in Pennsylvania, and later obtained an Executive Certificate in Leadership and Management from the MIT Sloan School of Management, USA.
H.E. AlJalajel also oversees the landmark transformation of health services in the Kingdom, following the Council of Ministers’ approval in June 2022 to establish the Health Holding Company and the National Health Insurance Center. The Health Holding Company delivers services through regional health clusters, while the Insurance Center finances them, ensuring a separation between regulator and provider. This shift is designed to enhance efficiency, effectiveness, and accessibility for citizens, residents, and visitors, and reflects a core step in advancing the Ministry of Health’s transformation strategy moving forward.
In alignment with the Kingdom’s Vision 2030, future healthcare initiatives will focus on expanding digital health, integrating AI-driven diagnostics, and enhancing primary healthcare networks to ensure sustainable and high-quality care for all residents.
The healthcare transformation in Saudi Arabia aims to shift its health system to become value-based, focusing on prevention of disease rather than treatment, ensuring broader patient coverage and better long-term health outcomes.
Steered by H.E. AlJalajel, technology and innovation in the sector are key. Recently, in September 2025, the Kingdom introduced robotic surgery at King Abdullah Medical City in Makkah.
The new robotic system is significant as it marks a major advancement in healthcare services provided to Hajj pilgrims and will support procedures in thoracic surgery, urology, and oncology. This will not only enable greater surgical precision, but facilitate faster recovery for patients.
The initiative is part of the Ministry of Health’s efforts to leverage technology to improve the quality and efficiency
of care delivered during the annual pilgrimage. The hospital has also launched the first-ever PET-CT scanner within the Ministry’s hospitals in the western region. The diagnostic tool allows for early detection of cancers, cardiovascular diseases, and neurological disorders, significantly enhancing diagnostic capabilities. These developments are fully aligned with the Kingdom’s Vision 2030, which emphasizes innovation and excellence in healthcare.


Driven by the belief that excellence is a daily commitment, Sherif Beshara, Group CEO of American Hospital Dubai is redefining standards in patient care at American Hospital Dubai and paving the way for the future of healthcare across the region.
Backed by a philosophy of harmony that aligns purpose, people, and performance, Beshara is a distinguished leader with extensive experience in the legal sector, holding a master’s degree in International Law. His professional journey, extending over a decade, includes roles as Legal Counsel, Chairman, and, most recently, Group CEO of the Mohamed & Obaid AlMulla Group of Companies. He drives transformation across the group’s departments, shaping strategic direction, leading internal audit and compliance programs, and helping develop overall management policies as a key member of the executive team.
Equally central is his drive for innovation, which he views as a crucial force shaping the evolution of healthcare. This outlook led the hospital, in 2020, to establish the region’s first AI-driven research center in partnership with Cerner. American Hospital Dubai was among the first in the region to recognize the significance of implementing AI-driven predictive medicine.
Beshara’s leadership at American Hospital Dubai reinforces Dubai’s emergence as a global hub for medical excellence. American Hospital Dubai has played a key role in this vision, operating medical tourism offices in Lagos and Nairobi, with plans to expand to 30 offices across Europe and Africa. Endorsed by the Dubai Health Authority, these offices enable patients to access high-quality medical care and innovative healthcare services, reinforcing Dubai’s reputation through the Dubai Health Experience brand.
American Hospital Dubai is a leading private healthcare provider in the Middle East, offering world-class medical services within a state-of-the-art, 252-bed acute care facility. With over 40 medical and surgical specialties led by American Board-certified or equivalent physicians, it maintains international standards of care.
Since its establishment in 1996, the organization has been committed to delivering world-class, patient-focused healthcare driven by innovation. Its esteemed hospitality division, featuring prominent hotel franchises such as IHT, enhances this commitment by accommodating medical tourists within its own hospitality properties. The integration of modern hospitality assets with advanced medical facilities has been a key factor in the organization’s ongoing success.
The hospital continues to expand its services to enhance personalized care, comfort, and convenience. In June 2016, it became the first Middle Eastern hospital to join the prestigious Mayo Clinic Care Network, enabling collaboration and expertise sharing to benefit regional patients. It was the first hospital in the region to receive JCI accreditation, and its medical laboratory was the first private lab in the Middle East accredited by the College of American Pathologists (CAP). American Hospital Dubai has established Centers of Excellence in cancer, heart disease, orthopedics, diabetes, and robotic surgeries, setting standards in complex disease management. Additionally, education and mentoring are prioritized to elevate medical standards and enhance patient care.
In the UAE’s knowledge-driven economy, education is essential. At American Hospital Dubai, continuous learning is a core focus. The hospital’s American Hospital Academic Institute (AHAI) has trained over 500 medical professionals and partners with top UAE universities, including the University of Sharjah, Mohammed Bin Rashid University, and Gulf Medical University, to nurture local talent. Additionally, AHAI is establishing a medical college in Dubai through a Memorandum of Understanding with Baylor College of Medicine and developing the UAE’s first Doctor of Medicine program.
Moreover, in 2021, American Hospital Dubai established the first robotic surgical training hub for the MEA region in partnership with Robotic Surgical Systems (RSS) and the UK-based CMR Surgicals, launching the region’s inaugural robotic surgery training hub and educational academy. In fact, American Hospital Dubai was the first private hospital in the UAE to introduce the da Vinci robotic system and is the region’s first private healthcare facility to receive accreditation from the US-based surgical review corporation (SRC).
Another vital sector driving the UAE’s healthcare prominence is medical tourism and aligned with this vision, American Hospital Dubai plays an instrumental role as a committed partner in advancing the nation’s medical tourism ambitions. They maintain medical tourism representative offices in Nigeria and Kenya and have led the AHD Global Initiative international medical tourism campaign in capitals such as London, Paris, Amsterdam, Frankfurt, Zurich, Milan, and Barcelona, promoting Dubai as a medical tourism destination.
In addition, American Hospital Dubai’s American Hospital Care Network (AHCN) offers third-party management services to other healthcare providers and facilities, helping to elevate standards across the region. To foster a culture of excellence in healthcare practices, American Hospital Dubai is proud to be the first hospital in the Middle East to implement this innovative concept of knowledge sharing and mentoring. This initiative not only enhances the quality of care provided but also promotes continuous learning and collaboration among healthcare professionals, ultimately benefiting patients and advancing medical standards in the region.

Leading by example, Dr. Shamsheer Vayalil is a healthcare visionary and successful entrepreneur who transformed Burjeel Holdings from a single hospital to an end-to-end healthcare provider with a rapidly expanding global footprint.
A trained radiologist with a passion for developing medical facilities and improving healthcare quality in the Middle East, Dr.
Shamsheer founded VPS Healthcare in 2007 with a vision to provide affordable and accessible healthcare services to those in need. Over the years, VPS Healthcare expanded into a comprehensive healthcare network with a presence across the GCC region, India, and Europe, operating numerous hospitals and medical centers with an expansive workforce.
In 2022, VPS Healthcare unified its GCC assets under a new holding company, Burjeel Holdings, to manage a wide range of healthcare brands. This consolidation has established it as one of the region’s largest integrated health networks, serving diverse socio-economic segments through various brands, including Burjeel Hospitals, Medeor Hospitals, LLH Hospitals, Lifecare Hospitals, Tajmeel, and PhysioTherabia, which was born out of a desire to provide cost-effective yet specialized and superior quality healthcare services. Under his guidance, the Group is rapidly emerging as a regional and global front-runner, building a robust healthcare ecosystem at home, attracting world-class expertise, and reducing the need for patients to travel abroad for treatment.
Dr. Shamsheer is a keen philanthropist with an active involvement towards helping communities and the underprivileged through a series of health-focused campaigns and initiatives. His philanthropic initiatives reflect his deep commitment to community welfare, from funding 50 free heart surgeries for children with congenital heart disease across Africa and Asia to supporting 10 life-changing osseointegration surgeries at Burjeel Medical City. Dr. Shamsheer recently extended $681,000 (AED 2.5 million) in aid to the students and families of BJ Medical College, who were affected by the Air India crash in Ahmedabad, standing with India’s medical fraternity in a time of crisis. His compassion has also touched the lives of individual patients,
including Sham and Omar, Syrian siblings rescued after the 2023 earthquake, whose treatment at Burjeel inspired wider access to advanced prosthetics and complex care in the region.
Recognized by key global and local accolades for his continuous pursuit of excellence in developing healthcare, philanthropy, and entrepreneurship across the region, Dr. Shamsheer received the Pravasi Bharatiya Samman Award, India’s highest civilian award presented to Non-Resident Indians. He is also a member of the UAE Medical Council and a member of the advisory committee of the University of Sharjah College of Medicine.
Burjeel Holdings is one of the leading private providers of world-class healthcare services in the UAE and Oman, with a growing specialized healthcare segment in Saudi Arabia. Burjeel Medical City, the flagship facility of Burjeel Holdings, houses globally recognized and reputed institutions, including the Paley Middle East Clinic, Advanced Gynecology Institute, FrancoEuropean Multidisciplinary Institute of Endometriosis (IFEM Endo), and Burjeel ENT Head & Neck Institute. Burjeel Medical City has become a leading destination for complex care, offering advanced treatments in oncology, transplants, orthopedics, women’s health, and other quaternary services supported by cutting-edge technology and international standards. With strong research capabilities, accredited programs, and comprehensive patient support from travel to follow-up, it attracts patients from across the Middle East, Africa, and Asia who need solutions beyond their home systems. Strategic collaborations and Abu Dhabi’s supportive healthcare ecosystem further strengthen its role in positioning the Emirate as a global hub for medical tourism, combining world-class outcomes with compassionate care.
According to its official website, Burjeel Holdings boasts 6.5 million patient footfall; 112 medical assets, including 20 hospitals; 1,775 doctors; 1,730 beds, and 82,000 total surgeries.
Burjeel Holdings accelerated its strategic initiatives in Q2 2025, focusing on deepening expertise and expanding patient access. The Group enhanced its advanced oncology network by integrating Dubai’s Advanced Care Oncology Center and launching the new Burjeel Cancer Institute clinics in Al Ain, Sharjah, and Oman, as well as the UAE’s first dedicated cancer pharmacy.
Simultaneously, Burjeel launched a regional mental health platform through its joint venture Alkalma, establishing four specialist centers across the UAE and KSA. This marked the beginning of a multi-year expansion plan to meet growing
“Dr. Shamsheer is a keen philanthropist with an active involvement towards helping communities and the underprivileged through a series of health-focused campaigns and initiatives.
demand for mental wellness services. In KSA, the Group acquired a major physiotherapy facility in Riyadh under PhysioTherabia, boosting capacity and unlocking growth potential through secured government contracts.
Patient demand continued to rise across IVF, oncology, and diagnostics, fuelling overall growth. Oncology revenue surged due to network expansion and improved surgical conversion rates. The Group invested approximately $46.3M (AED 170M) to acquire the Medeor Hospital Dubai building, and also expanded primary care with a new medical center on Saadiyat Island, aligning with its urban growth strategy.
In innovation, Burjeel launched DOCKTOUR, a healthcare logistics joint venture with AD Ports Group, aimed at serving underserved and remote communities. Several specialized centers were launched, including the region’s first Al Muderis Osseointegration Clinic for limb reconstruction and a state-of-the-art Epilepsy Monitoring Unit. The Group expanded its capabilities in rare diseases, hematology, and metabolic research. Additionally, Burjeel advanced its digital transformation with AI-powered diagnostics and led pioneering research in microgravity, aiming to revolutionize diabetes care on Earth and in space. More healthcare innovations include the Group’s center for Robotic Surgery, equipped with the latest Da Vinci XI Robotic System and highly skilled board-certified robotic surgeons.
Burjeel Holdings achieved a significant milestone on 8 September 2025 with the accreditation from the National Institute for Health Specialties (NIHS) for its Internal Medicine and General Surgery residency programs. This expands the Group’s existing portfolio, which already includes approved programs in Orthopaedics and Haematology-Oncology Fellowships. The Group also announced the launch of its postgraduate residency and fellowship programs across four key medical disciplines, demonstrating its commitment to fostering the UAE’s next generation of healthcare professionals.
Founder & Chairman, Aster DM Healthcare

Under his transformational leadership, Dr. Azad Moopen has been instrumental in advancing the ever-evolving healthcare landscape of the GCC, India, and beyond, setting new benchmarks for innovation.
Dr. Moopen has dedicated nearly five decades to transforming healthcare, led by a vision based on innovation, compassion, and service. Born in Kerala, India, in 1953, he completed his MD in General Medicine as a Gold Medalist and earned a diploma in Chest Diseases.
In 1987, a visit to Dubai revealed the pressing need for accessible and quality healthcare, especially among the expatriate community. What began as a single clinic in Bur Dubai ultimately transformed into Aster DM Healthcare, one of the largest integrated healthcare providers across the GCC and India, making quality care accessible across income groups without compromising medical excellence.
Under his visionary leadership, Aster DM Healthcare has expanded into a global network of more than 963 facilities
across seven countries. The organization’s comprehensive “circle of care” includes more than 36,600 professionals, including 5,315 doctors and 10,294 nurses, across 34 hospitals, 134 clinics, 536 pharmacies, and 259 labs and patient experience centers. Beyond infrastructure, Dr. Moopen has consistently emphasized education, research, and training as key drivers of sustainable healthcare delivery.
Committed to social responsibility, Dr. Moopen’s legacy extends far beyond business. In 2017, he established the Aster Volunteers initiative, which has evolved into a global force of over 85,000 volunteers, extending healthcare services and relief to underserved populations and disaster-affected regions. As the global CSR arm of Aster DM Healthcare, this initiative embodies the spirit of giving back to society and has touched the lives of over 6.9 million people through various programs that include disaster relief efforts, mobile medical services, and more.
Dr. Moopen’s belief that “profit is a by-product, not the purpose” is deeply ingrained in his corporate ethos. Through Aster DM Foundation and Dr. Moopen Family Foundation, he has dedicated 20 percent of his personal wealth to philanthropy, supporting projects in healthcare access, education, and community development.
His contributions have been recognized with some of India’s and the region’s highest honors, including the Padma Shri, the Pravasi Bharatiya Samman, and recognition among the 100 Most Inspiring Leaders in the Middle East. Recently, he joined India’s top five promoter-investors, with his financial growth reflecting the sustainability of purpose-driven enterprise.
For over four decades, Dr. Moopen has championed a vision that healthcare is more than a business, it is a noble service dedicated to saving lives, restoring wellness, and uplifting communities.
As Aster DM Healthcare moves into its next growth chapter, Dr. Azad Moopen stands as a true healthcare visionary, proving that with compassion, vision, and unwavering commitment, it is possible to build an enterprise that heals millions while creating lasting social and economic impact.
As the GCC rises as a global hub, Aster DM Healthcare is recognized as one of the region’s most influential integrated healthcare providers, with a presence spanning the Gulf and India. Headquartered in Dubai, it operates 15 hospitals, 124 clinics, and 333 pharmacies, serving over 17 million patients across GCC annually. Its diverse portfolio spans primary to quaternary care, alongside diagnostics, retail, wellness, and digital health platforms, delivering accessible, world-class healthcare across all levels.
In the GCC, Aster operates under well-recognized brands such as Aster, Medcare, and Access Clinics. The company completed a landmark restructuring in April 2024, with a Fajr Capital–led
consortium acquiring a majority stake in its GCC operations. Despite this shift, Aster’s Gulf network continues to thrive with a strong portfolio of hospitals and clinics. The group is also driving significant expansion in Saudi Arabia, with a planned $266.5M (SAR 1BN) investment over the next few years to establish 180 pharmacies, five new hospitals, and 30 medical centers, supported by the rollout of the myAster digital platform. This expansion, aligned with Vision 2030, will integrate telehealth, pharmacy and wellness product delivery, and AI-powered innovations, while creating approximately 4,900 new jobs and reinforcing Aster’s focus on accessible, customer-centric healthcare.
Recently, Aster Volunteers launched its 64th and 65th Mobile Medical Units to serve communities in Rwanda and Uganda. The mobile units, equipped with telehealth and other advanced medical facilities, will provide free healthcare services to marginalized communities in these countries.
In India, the Group operates 19 hospitals with over 5,197 beds, alongside 10 clinics, 203 pharmacies (operated by Alfaone Retail Pharmacies Private Limited under brand license from Aster), and 259 labs and patient experience centers. With a workforce of over 22,400 professionals in India alone, Aster has committed to an ambitious expansion plan to increase capacity over 13,600 beds over the coming years. This includes the development of new hospitals in Bengaluru, Kerala, and Hyderabad, as well as entry into smaller cities where demand for quality healthcare is rising. The planned merger with Quality Care India Ltd. (QCIL) is expected to create one of India’s top three hospital chains, with over 10,366 beds and a robust pipeline for future growth.
From being recognized among the world’s best hospitals to shaping the future of healthcare in India, Aster DM continues to expand its impact with a long-term vision of quality, accessibility, and excellence in patient care.
“Dr. Moopen has dedicated nearly five decades to transforming healthcare, led by a vision to serve the world with quality healthcare that is easily accessible.
Cofounder & Group CEO, PureHealth

“Under Asif’s visionary, PureHealth is committed to creating a future where people thrive in well-being toward a healthier and longer life.
Apioneer in redefining healthcare, Shaista Asif has propelled PureHealth to become the fastest growing and the most diversified healthcare group in the region, committed to a sustainable future.
In her role at PureHealth, the largest healthcare group in the region, Asif is at the forefront of revolutionizing healthcare across the Middle East and beyond. She spearheads a comprehensive portfolio, comprising over 110 hospitals, over 316 clinics, multiple diagnostic centers, health insurance solutions, pharmacies, health tech, procurement, and strategic investments.
She has led the development and implementation of pioneering innovations and strategic healthcare acquisitions across multiple regions, including the Middle East, the UK, the US, Greece, and Cyprus. Through her vision and leadership, she has played a pivotal role in transforming PureHealth into the fastest growing and most diversified healthcare group in the Middle East, and also establishing a strong presence in global healthcare markets.
Also, Asif steered the successful investment in Ardent Healthcare in the United States, and also led a deal worth over $ 1.2 billion in a landmark acquisition of Circle Health Group, the first-of-its-kind healthcare acquisition by a UAE-based group in the UK. Her visionary strategies led to her orchestration of PureHealth’s successful initial public offering (IPO) in 2023.
She has been at the forefront of PureHealth’s consolidation efforts, executing the group’s strategy for quality excellence, growth, as well as development, and her accomplishments has earned her multiple accolades and recognitions in key media platforms.
Her direction has led PureHealth’s commitment to a sustainable future, becoming part of the United Nationsbacked Race to Zero initiative for Climate Change, and also pledging Net Zero emissions by 2040. Moreover, she also spearheaded several AI-driven initiatives, aligned with PureHealth’s vision, including the region’s first AI-backed healthcare companion app- Pura, which is helping people live healthier, longer lives.
PureHealth is the largest healthcare group in the Middle East with an ecosystem that challenges lifespans and reimagines health spans. With more than 110 hospitals, over 316 clinics, multiple diagnostic centers, health insurance solutions, pharmacies, health tech, procurement, investments and more, its ground-breaking innovations are at the forefront of healthcare as the company is on a mission to unlock time for humankind. By advancing the Science of Longevity, PureHealth is introducing the healthcare of the future from the United Arab Emirates to the rest of the world.
PureHealth’s network comprises SEHA, one of the largest healthcare networks of hospitals and clinics in the UAE; SEHA CLINICS, delivering comprehensive communitybased healthcare services; Daman (The National Insurance Company), the UAE’s leading health insurer; and The Medical Office, overseeing Sheikh Khalifa Hospitals and healthcare facilities established under the initiatives of H.H. The President of the UAE. Also, Rafed, the UAE’s largest healthcare Group Purchasing Organization; PureLab, managing and operating the largest network of laboratories in the region; One Health, a network that provides end-to-end medical solutions to a base of over 300 healthcare service providers; The Life Corner, Abu Dhabi’s first holistic pharmacy, serving the health and wellness establishment; and Ardent Health Services, the fourth largest privately held acute care hospital operator in the US. As well as Circle Health Group, the largest independent operators of hospitals in the UK; Hellenic Healthcare Group (HHG), the largest private healthcare provider in Greece and Cyprus; PureCS, a leading cloud and technology services provider, specializing in IT management and consulting solutions, cybersecurity, cloud services as well as AI information systems, as well as Sheikh Shakhbout Medical City (SSMC), the UAE’s largest healthcare complex, delivering integrated complex care.
With a global network and a commitment to innovation, PureHealth aims to improve well-being as well as promote longevity through its services. Through thoughtful investments and forward-thinking strategies, PureHealth’s vision is to drive long-term growth, enhance quality of life worldwide, and deliver healthier, longer, and more fulfilling lives.
According to the Abu Dhabi Media office, *PureHealth has strategically expanded its insurance arm, Daman, which demonstrates its transformation from a healthfocused provider into a comprehensive, multi-line insurer with a foray into the high-growth Property and Casualty (P&C) segment. As part of this expansion, Daman will adopt a new legal name: The National Insurance Company – Daman. As the insurance arm of PureHealth and the UAE’s leading health insurer, Daman’s expansion into the P&C segment highlights its vision to become a comprehensive insurance provider and reflects the group’s commitment to deliver coverage and holistic care during all stages of life.
In terms of expansion, the UAE’s P&C insurance market is set for further accelerated growth, which is projected to reach around $16.8 billion by 2031, according to Verified Market Research. To align with this growing demand, the company will continue to operate under the Daman brand, launching new P&C products in stages while ensuring uninterrupted service for existing members.
Group CEO & Board Member, Fakeeh Health CEO, Fakeeh University Hospital
Apioneer in the healthcare fraternity with over 25 years of global healthcare leadership at the executive level, Dr. Mohaymen Abdelghany’s robust expertise as a C-suite senior physician is driving innovative solutions across the global healthcare sector.
Backed by a wealth of experience, Dr. Abdelghany has led and worked with complex healthcare systems across Egypt, KSA, UAE, India, and the USA. He is widely recognized for building high-performing, patientcentered organizations and driving transformative change across both public and private sectors.
Throughout his career, Dr. Abdelghany has held key leadership roles, including launching and scaling multi-site hospital networks at Saudi German Hospital in Riyadh, Abha, and Dubai; enhancing access and clinical services at Al Sharq Healthcare, Fujairah; as well as leading growth at the Center of Excellence development at Al Zahra Hospital, Dubai. He was also responsible for transforming operations at Danat Al Emarat Hospital & Clinics, a Mubadala Health partner; designing the facility and care delivery model at Mietra Hospital, Calicut-India; and also, led the expansion of King’s College London Hospital’s platform in KSA, aligning UK standards with regional needs.
In addition to his executive roles, he serves as a Physician Consultant with the Joint Commission International (JCI), advising hospital systems worldwide on clinical governance, quality, and accreditation. He is an active member of several regional and international advisory boards, contributing thought leadership on healthcare innovation, policy, and sustainability. Dr. Abdelghany is also a frequent keynote speaker and panellist at leading healthcare conferences and summits, where he shares insights on strategic growth, digital transformation, and peoplefirst leadership.
His contributions to the field have earned several honors and he has been recognized by a key government entity as Distinguished Chief Executive in Healthcare, and recognition among LinkedIn’s Most Powerful Profiles in the UAE. As a respected voice in the global healthcare community, Dr. Abdelghany continues to champion healthcare transformation built on trust, purpose, and an unwavering commitment to excellence.
He holds dual master’s degrees in Anesthesia and Healthcare Management and is an alumnus of Harvard University’s executive programs in healthcare leadership and strategy. He has also completed strategy and leadership development programs at INSEAD, bringing together clinical expertise and global strategic acumen.
Fakeeh Health is a pioneering healthcare group in the UAE, carrying forward a legacy of over 48 years rooted in clinical excellence, research and innovation, and academic integration. Built on compassion and advanced medical expertise, Fakeeh Health stands as one of the fastestgrowing healthcare corporations in the region and is recognized for operating the largest private-sector hospital.
At the heart of Fakeeh Health is Fakeeh University Hospital, a world-class, technology-enabled academic hospital located in Dubai Silicon Oasis. Extending healthcare into communities, Fakeeh Medicenters provide specialized and primary care with plans to expand into more branches across the UAE. Innovation-driven Fakeeh Smart Clinic delivers convenient, digitally enhanced patient experiences, while the upcoming Fakeeh DaySurge introduces advanced same-day surgical care for greater accessibility.
EXCELLENCE & COMMITMENT
Fakeeh Health is committed to elevating the standards of healthcare by investing in cutting-edge technologies, creating a healing environment, and ensuring excellent clinical outcomes. With a strong emphasis on patientcentered care, the group is dedicated to delivering an exceptional patient experience that combines compassion with world-class expertise.
Fakeeh Health has established itself as a benchmark in private healthcare, recognized as one of the fastest-growing corporates in the sector. Its growth is guided by a strong healthcare system model, setting standards in quality, efficiency, and accessibility. As part of its long-term vision, Fakeeh Health continues to introduce innovative healthcare models, expand its facilities, and integrate technology to transform care delivery.
ACADEMIC APPROACH
Fakeeh Health is proud to hold internationally recognized accreditations that reflect its unwavering commitment to excellence and quality in healthcare. These include
accreditations from the Joint Commission International (JCI), the College of American Pathologists (CAP), the American Nurses Credentialing Center (ANCC), and ISO certifications, alongside recognition by HIMSS, ASHSP, and the U.S. Green Building Council (LEED Gold).
Fakeeh Health has also received a 5-Star Hospital Rating this year, by Newsweek in partnership with Statista, further
reinforcing its commitment to excellence in patient care and clinical outcomes.
The Group is also honored to be recognized as a Great Place to Work®, further underscoring their commitment to fostering a culture of care and innovation.
Aligned with their vision of integrating healthcare with education, Fakeeh Health established the Fakeeh College

of Medical Sciences – Nursing Program, cultivating the next generation of skilled and compassionate nurses.
Building on this foundation, their future plans include expanding academic initiatives and introducing more specialized educational programs that combine practical training, research, and innovation, ensuring continuous growth in medical knowledge and healthcare excellence across the UAE.
“A pioneer in the healthcare fraternity with over 25 years of global healthcare leadership at the executive level, Dr. Mohaymen Abdelghany’s robust expertise as a C-suite senior physician is driving innovative solutions across the global healthcare sector.
Dr. Thumbay Moideen’s entrepreneurial journey is a distinguished example of vision, perseverance, and leadership. Coming from a traditional business family in Karnataka, he ventured into entrepreneurship at the age of 21. In 1997, with the support of the Rulers of Ajman, he established Thumbay Group and went on to found Gulf Medical University (GMU), the region’s first private medical university.
From its beginnings as a single university, Thumbay Group has grown into a fully integrated academic health system that combines education, healthcare, and research. GMU today attracts students from more than 106 countries and offers 35 accredited programs, ranging from doctoral and master’s degrees to undergraduate, diploma, and foundation courses.
Students benefit from clinical training at 45 affiliated sites, including Thumbay University Hospital, Thumbay Dental Hospital, and other JCI-accredited facilities. Supporting this ecosystem is the Thumbay Research Institute for Precision Medicine, which leads work in genomics, cancer biology, and personalized medicine. Anchored by Thumbay Medicity in Ajman, GMU also houses advanced hospitals, research centers, rehabilitation facilities, and the Thumbay Institute of LASIK & Eye Surgery.
Over the past 28 years, Thumbay Group has expanded into multiple sectors, including healthcare, medical research, retail pharmacy, retail optical, wellness, nutrition, veterinary services, medical tourism, hospitality, publishing, media, real estate, and events. Today, the Group employs approximately 4,000 professionals and treats patients from more than 175 nationalities, making it the largest private academic healthcare network in the region.
Recent developments include the establishment of Thumbay International Pathway program and Thumbay College of Management & AI in Healthcare, currently 6 colleges and two more colleges coming soon the Thumbay Fergana College of Medical Sciences in Uzbekistan, in collaboration with the Fergana Medical Institute of Public Health. This initiative aims to expand medical education and healthcare services in the region, fostering local talent and enhancing healthcare standards.
Additionally, the launch of the Thumbay Veterinary Clinic in Sharjah marks a significant step toward developing
a comprehensive veterinary hospital and a veterinary college under Gulf Medical University. This facility will provide advanced veterinary care and serve as a training hub for future veterinarians, supporting the growing need for animal health services in the region.
Furthermore, the introduction of the Thumbay College of Healthcare in AI represents a pioneering effort to integrate artificial intelligence into medical education. This program is designed to prepare future healthcare professionals with cutting-edge knowledge and skills in AI applications, positioning them at the forefront of technological innovation in medicine.
As an integral part of its strategic ecosystem, the Thumbay College of Management and AI in Healthcare collaborates with over 15 top industry partners. These partners, comprising health-tech innovators, AI solution providers, and academic institutions, play a key role in fostering practical learning experiences and supporting the development of projects that are directly aligned with industry needs.
Dr. Moideen has been honored with five honorary doctorates, exemplifying his significant contributions to the fields of medical education, healthcare, and research. The most recent accolade was awarded by the University of Lublin in Poland, in recognition of his impactful work in advancing medical sciences and fostering international collaborations that benefit the global healthcare community.
Through the Thumbay International Research Grant (TIRG), the Group demonstrates its strong commitment to advancing medical research and innovation. Currently, the Group invests approximately $817,000 annually in supporting pioneering research projects across various disciplines. This substantial funding aims to accelerate breakthroughs in critical areas such as precision medicine, cancer immunology, drug discovery, diabetes management, and healthy aging, and the establishment and foundation of Thumbay Research Block housing the latest research Infrastructure.
Looking ahead, the Group has ambitious plans to expand this research investment to a total of $2.7 million, reinforcing its dedication to fostering cutting-edge scientific advancements and improving patient outcomes worldwide. The TIRG program not only provides essential financial support but also encourages collaboration among researchers, institutions, and industry partners
to drive innovation as well as translate discoveries into real-world healthcare solutions and to Fund Start-ups through the Thumbay Incubation Center.
As Thumbay Group marks 28 years of growth, Dr. Moideen continues to pursue his vision of expanding globally while remaining true to the Group’s core mission: to build institutions that combine innovation with compassion. His leadership has positioned Thumbay Group as a model for accessible, high-quality healthcare and education, serving as a blueprint for other regions and leaving behind a legacy defined by lives transformed.
As an integral part of its strategic ecosystem, the Thumbay College of Management and AI in Healthcare collaborates with over 15 top industry partners.
As part of its expansion efforts, on September 4, 2025, Thumbay University Hospital launched the Thumbay Institute of LASIK & Eye Surgery at Thumbay Medicity, Ajman. The institute offers services including LASIK, PRK, SMILE, corneal cross-linking, refractive cataract surgery with advanced IOLs, and more. As both a clinical and academic center, with plans for certification courses, fellowships, and simulation training, research will focus on refractive outcomes, AI-driven nomograms, ocular surface disease, and presbyopia, contributing to global knowledge. The institute is establishing international partnerships for training, multicenter trials, and knowledge sharing to deliver care aligned with global standards and also to grow its Healthcare Business to 5X in the Near Future.

Zone President EAGM (Eurasian and African Growth Markets), GE HealthCare

Driven by GE HealthCare’s vision of limitless healthcare, Kostas Deligiannis is steering the growth of the company through smart devices, cutting-edge medical technology, and forward-thinking care solutions.
Backed by a focus on expanding access and impact through intelligent healthcare solutions that support a future without limits, Deligiannis boasts a wealth of experience. As a seasoned veteran, he plays a pivotal leadership role in leading a team of over 2,000 people across more than 50 countries across EAGM, including the Middle East, SubSaharan Africa, Turkey, Russia, and the CIS.
Since his formative years, Deligiannis has maintained an unwavering commitment to excellence, which continues to drive his success. From 1998 to 2001, he worked in CNRS (Center National de la Recherche Scientifique) in Grenoble (France) in the domain of superconductivity, having been awarded the European Union Marie Curie Fellowship. He has also been also honored with the Bodossaki Foundation Scholarship.
Deligiannis initiated his career at GE Healthcare in 2003 and with dedication and persistence, quickly climbed the ranks to the role of Sales Manager for Greece. His leadership trajectory began in 2010 as Zone Manager for Central and West Balkans. In 2013, he was promoted to General Manager for Southeastern Europe, and five years later, he took on broader responsibilities as General Manager for Eastern Europe. His appointment as Zone President in 2024 marked the next step, managing a wide and diverse region spanning the Middle East, Northeast & Sub-Saharan Africa, Turkey, Russia, and the CIS.
With an academic background that is equally impressive with Deligiannis having graduated in 1994 from the Physics Department of Athens University in Greece. He was awarded with a PhD in Solid State Physics from the University of Southampton (UK), where he also worked as a Researcher for one year.
Exemplifying a leadership style aligned in both people and performance, Deligiannis spearheads GE HealthCare’s growth initiatives by harnessing cutting-edge technologies, innovative digital health solutions, and scalable care models. This has helped solidify GE HealthCare’s position as a pioneer in healthcare innovation.
As a leading medical technology and diagnostics innovator, GE HealthCare enables clinicians to make faster, more informed decisions through intelligent devices, data, analytics, applications, and services, supported by its Edison intelligence platform. They provide imaging, diagnostic, monitoring, digital solutions, and devices worldwide and invests $1 billion in R&D annually.
Serving patients and providers for more than 100 years, GE HealthCare is advancing personalized, connected, and compassionate care, while simplifying the patient’s journey across the care pathway. Together, their imaging, ultrasound, patient care solutions, and pharmaceutical diagnostics businesses help improve patient care from prevention and screening, to diagnosis, treatment, therapy, and monitoring.
Overall, revenue growth was driven by strength in the US and Europe, the Middle East and Africa with Q2 2025 global revenues reflecting $5.0 billion with a 3 percent increase reported yearover-year. Net income attributable to GE HealthCare was $486 million versus $428 million for the prior year.
With over 51,000 employees, over 200 imaging software applications, and serving customers in over 160 countries, GE HealthCare has been a partner to the MENEAT region for over 80 years. Throughout key markets in the region, including the UAE, GE HealthCare is revamping existing hospital practices and accelerate diagnostics and treatment by the expansion of its range of artificial intelligence (AI) and machine learning systems and devices. By providing intelligent solutions to healthcare facilities in these countries, the company is helping them achieve greater efficiency, minimise errors, and enable better patient care.
Backed by game-changing innovations in digital technologies that are addressing unique healthcare challenges of the region, in July 2025, Dubai Health and GE HealthCare signed a Memorandum of Understanding (MoU) to collaborate on enhancing Point-of-Care Ultrasound (POCUS) practices and are co-developing AI solutions to support clinical decision-making, ultimately enhancing patient care and outcomes across the UAE and the MENA region.
Combining Dubai Health’s academic and innovation expertise with GE HealthCare’s advanced technological capabilities, the UAE and the broader MENA region will result in enhanced medical education, reinforced clinical decision-making, and improved health outcomes. Also, this will establish Mohammed Bin Rashid University of Medicine and Health Sciences (MBRU) as a pioneer in Point-of-Care Ultrasound education and a POCUS Education Center of Excellence across the MENA region. One of the key initiatives will include a ‘Train-of-Trainer (TOT)’ structured program to build capacity in certified facilitators and trainers to enhance the effectiveness of POCUS program delivery and execution across a broader geographical region.
Moreover, this collaboration will supplement the codevelopment of AI solutions through Dubai Health Innovations. This supports transformative solutions that improve patient care, bolster medical advancements, and enhance health outcomes. Ultimately, the adoption of cutting-edge AI tools and technologies will contribute to the advancement of healthcare delivery in the region.
Managing Director & CEO, Global Fertility and Co-founder & Chairman, Ovasave

Instrumental in driving advancements in fertility, reproductive medicine and women’s health on a global scale, Majd Abu Zant is the Managing Director & CEO of Global Fertility, a Healthcare Investment Venture specializing in fertility and women’s health; and the Cofounder & Chairman of Ovasave, the region’s first femtech startup focusing on fertility and reproductive medicine, both recognized as pioneers in the field.
Pushing boundaries in areas that were once considered taboo in the region, Abu Zant is a trailblazing figure in the field of fertility and women’s health. He founded Global Fertility to expand access to advanced reproductive treatments throughout the GCC through a unified network under the name of Bnoon. Over one decade ago, he launched HealthPlus Fertility as a regional IVF brand, helping thousands of families achieve their dream of parenthood through safe, top-quality care.
Also instrumental in developing and opening several hospitals and clinics across the UAE and KSA, one of Abu Zant’s missions was to increase the capacity for fertility and specialty care in both markets.
In 2023, he also co-founded Ovasave, a femtech platform dedicated to making fertility preservation and hormone care accessible to women across the MENA region.
Backed by over 27 years of diverse, strategic, and results-driven leadership experience within the healthcare industry, Abu Zant is also recognized as a respected thought leader, global mentor, and expert in the field. Having established collaborations with prominent international healthcare institutions across Asia, Europe, and North America, he has driven robust partnerships and contributed to the development of innovative healthcare services and world-class facilities.
Prior to founding Global Fertility and OvaSave in 2023, Abu Zant was CEO of UEMedical, overseeing over 100 healthcare facilities across the UAE and KSA. Under his leadership, UEMedical became a leader in women’s and children’s health with the launch of Danat Al Emarat Hospital, and HealthPlus Network in addition to Moorfields Abu Dhabi. In 2022, he successfully led UEMedical’s exit to Mubadala in one of the region’s largest healthcare transactions.
By 2030, Abu Zant has set his sights on elevating women’s health and fertility care across the Middle East, a responsibility he has embraced through Global Fertility, Bnoon, and Ovasave. In less than 18 months, under Global Fertility, he has unified two major IVF acquisitions in Riyadh and Jeddah under the Bnoon brand, now KSA’s largest stand-alone fertility network delivering 5,000 IVF cycles a year. In parallel, he closed a $1.2 million preseed round in 2025 for Ovasave which has already helped thousands of women gain access to knowledge and tools once considered out of reach.
Global Fertility is a Saudi-Emirati healthcare investment venture focused on building the leading network of fertility and
reproductive genetics centers across the MENA region.
Under Abu Zant’s leadership and vision toward accelerating assisted reproductive technologies, IVF, and innovative women’s healthcare in the region, Global Fertility secured $60 million in equity financing to allow its expansion across the MENA region from prominent Saudi and Emirati-based institutional investors, family offices and UHNIs to build a MENA-wide network of fertility clinics. Moreover, Global Fertility secured an investment by Dubai Investments, the leading investment company listed on the Dubai Financial Market (DFM) of an equity stake of 34.3 percent in 2024.
In 2024/2025, Global Fertility acquired majority stakes in two leading standalone IVF centers in Riyadh and Jeddah for $27M. Global Fertility is also launching its flagship project in Riyadh that will set a new benchmark in fertility care and reproductive genetics across the region. Here, Abu Zant implemented energy-efficient and sustainable building design; deploying the latest in AI-driven clinical applications and robotics within its embryology and genetics labs. This purpose-built, 3,800 m2 facility, due to open early 2026, will create a new benchmark for fertility care across the region. Global Fertility invested $5M in digital transformation, bringing the latest technologies in embryology, reproductive genetics, and fertility preservation. Abu Zant also partnered with leading global institutions to advance training and research and deploy novel technologies, including wearables, robotics and AI-enabled clinical applications in reproductive medicine for the first time in the region.
OvaSave is a pioneering Hub71 Femtech start-up dedicated to advancing reproductive medicine and women’s health. Most recently, Abu Zant and his co-founder, Torkia Mahloul, recently closed a pre-seed round securing $1.2M in Ovasave led by prominent investors to expand its fertility and hormonal health services. Founded in 2023, Ovasave offers women a seamless, digital-first experience for fertility testing, egg freezing, hormone management, and menopause care. The platform combines at-home hormone testing, virtual consultations, personalized supplement protocols, and access to top fertility clinics for fertility preservation (egg freezing). Positioned as disruptors in fertility and women’s hormonal health, Ovasave has also established a growing corporate benefits scheme that helps organizations support employees’ reproductive health as part of their workplace wellbeing programs.
“Pushing boundaries in areas that were once considered taboo in the region, Abu Zant is a trailblazing figure in the field of fertility and women’s health.
Zaid S. Al Khayyat is the Managing Director of Al Khayyat Investments (AKI), leading the company through a transformative era of growth and innovation. Building on the legacy and founding principles of his father, Dr. Saad F. Al Khayyat, a surgeon by education who remains Chairman, Zaid has redefined AKI’s strategic direction while staying true to its roots as a family business at heart and run as a corporate multinational.
Under Zaid’s leadership, AKI has embraced a forward-thinking vision centerd on a people first culture, innovation and investment in the youth. He has cultivated an environment that inspires teams to excel and reach unprecedented heights, guided by his belief that “The moment learning stops, falling behind begins.”
AKI’s healthcare portfolio is one of the leading healthcare businesses in the UAE and the Middle East and has grown significantly over the last few years. Today, AKI Healthcare spans multiple businesses and geographies, including AKI Pharma, one of the UAE’s fastest-growing pharmaceutical distributors, Medlab, powering innovation across medical equipment and diagnostics, and a network of more than 150 BinSina retail pharmacies. Zaid focuses on where real benefit can be delivered, advancing innovation, reliable medicines supply, and patient centerd solutions across the UAE and the wider region.
Born and headquartered in Dubai, Al Khayyat Investments (AKI) embodies the UAE’s dynamic spirit, energy, and optimism. Founded in 1982 by Dr. Saad F. Al Khayyat, AKI has transformed from a single pharmacy to a multibillion-dollar diversified business. Al Khayyat’s entrepreneurial vision, people-first approach, and strong family values remain central to AKI’s operations, guiding its growth and strategic direction today.
Under the leadership of Al Khayyat, AKI operates as a multinational family-owned Emirati holding company. Its extensive portfolio covers multiple sectors, pharmaceuticals, medical equipment,
retail, food and non-food consumer goods, fitness, automotive, environmental services, logistics, manufacturing and contracting.
As one of the region’s most impactful UAE businesses, AKI serves as a trusted regional partner for multiple international and local brands, facilitating their expansion across the Middle East and Africa, a footprint that includes the UAE, Saudi Arabia, Qatar, Bahrain, Kuwait, Oman, Egypt, Jordan, and Iraq. Today, the Group boasts over 11,000 employees; over 70 nationalities; with 30 percent of our workforce women and an 85 percent ‘Great Place to Work’ score.
Most recently in 2025, AKI launched AKI Logistics focusing on third-party logistics (3PL) and AKI Creates a local manufacturing arm playing its part in the ‘Make it in the Emirates’ vision. Al Khayyat’s vision is clear where AKI sees opportunity and know they can add value, they will. Over the last year in particular AKI has gained significant momentum in Saudi Arabia, across the retail, consumer, healthcare, and fitness sectors.
Steered by Al Khayyat’s passionate belief in family values, at the heart of AKI’s success, lies its focus on core values, embedded in a people-first philosophy. AKI has harnessed new technologies to provide digital-first, mobile-enhanced consumer experiences.
Adapting to the ‘moments’ economy’s focus on customer experiences, AKI has longstanding partnerships with brands in Medlab Stryker, Boston Scientific, Solventum amongst others. And in AKI Pharma Novartis, Abbott, Bayer amongst others. With the Group’s alignment with the demand for holistic healthcare has witnessed an upward growth trajectory for AKI Healthcare across AKI Pharma, BinSina Pharmacy, and Medlab in Medical & Laboratory equipment.
Moreover, AKI’s Consumer Goods division ranks among the UAE’s top three FMCG growth partners representing brands such as L’Oréal, General Mills, Shark Ninja and Haleon to name a few, while BinSina Pharmacy has emerged as the UAE’s first e-commerce licensed pharmacy and this month

“Under Zaid’s leadership, AKI has embraced a forward-thinking vision centered on a people first culture, innovation and investment in the youth.
celebrates its 60th anniversary. In recent years, AKI Pharma increased its brand partnerships fourfold in five years, including adding gene therapy and patented radio therapy. Then the introduction of Abbott Freestyle Libre expanded its development even further. Additionally, AKI Environmental achieved a six year contract with Abu Dhabi Department of Municipality. AKI Contracting through Gulf Contracting and Landscaping (GCL) has seen continued growth through partnerships. Subsequently, GCL now operates a total of five plant nurseries with a footprint now exceeding 3 million sqft, collectively nurturing over a million climateadapted plants.
In Q1 2025, Al Khayyat Investments (AKI) launched a state-of-the-art Fulfilment & Innovation Center in Dubai Industrial City, part of TECOM Group. Spanning 1 million square feet, the facility doubles AKI’s fulfilment capacity in the UAE and improves efficiency and delivery speed, establishing and setting new benchmarks in agile and sustainable supply chain operations.
The center serves over 30,000 business customers and also provides directly to consumers. It currently maintains a 98.5 percent on-time delivery rate for orders requested within 24 hours. Supported by a fleet of over 150 vehicles, the facility processes 65,000 orders each month, shipping approximately 17 million units.
The new center aligns with Dubai’s D33 economic agenda by leveraging the city’s strategic location. It showcases AKI’s leadership in digital transformation and sustainability, featuring a fully paperless environment, automation technologies, and smart design elements like pick-to-light systems, multitier conveyor belts, dynamic bin replenishment, and drone-based inventory checks, all of which significantly enhance operational productivity.

As the CEO of Cleveland Clinic Abu Dhabi, Prof. GeorgesPascal Haber, MD, PhD, is also a renowned urologist specializing in robotics. He leads the organization’s efforts in driving strategic growth, clinical excellence, and innovation, with a core focus on technology-enabled, high acuity care.
Leading a team of 6,000 caregivers, Prof. Haber is a pioneering surgeon renowned for numerous medical firsts, including the first scar-free removal of a healthy kidney for transplant in Europe, the first large series of scar-free kidney and prostate surgeries performed through the navel, and the UAE’s inaugural
robotic kidney transplant. He has also achieved key milestones at Cleveland Clinic, such as the first robotic intracorporeal urinary diversion, robotic auto-transplant, and robotic Level 3 IVC thrombectomy. Committed to advancing medical research and education, Prof. Haber has authored over 250 peerreviewed articles, served as a visiting professor in more than a dozen countries, and led one of the top-ranked academic urology programs in the US.
Prior to his current role, Prof. Haber served as Chairman of the Glickman Urological & Kidney Institute at Cleveland Clinic

in Ohio. Under his leadership, the institute sustained its global reputation as a top ranked urology center and became home to the largest urology training program in the United States.
Prof. Haber completed his executive education at Wharton and Harvard Business Schools; his clinical fellowship in robotic urologic surgery at Cleveland Clinic; and his Master of Science in Surgical Oncology, PhD in Biotechnology, and medical training in France. His academic achievements reflect his deep commitment and passion to medical research and education. Prof. Haber’s career underscores a dedication to innovation, knowledge-sharing, and the advancement of surgical science.
Cleveland Clinic Abu Dhabi offers a distinctive and unmatched extension of the US-based Cleveland Clinic’s Model of Care, providing patients with direct access to world-class healthcare and eliminating the need to travel abroad for care. Recognized as the UAE’s first institution for clinical and medical innovation, it comprises eight institutes operating under the Patients First philosophy and address the region’s specific healthcare needs. The hospital encompasses over 50 medical and surgical specialties, all integrated to deliver coordinated, multidisciplinary care for adult patients.
Equipped with state-of-the-art facilities and world-class service standards, Cleveland Clinic Abu Dhabi is a 405 bed hospital, with capacity to expand to 490 beds. It features five clinical floors, three levels dedicated to diagnostics and treatment, and 13 floors of critical and acute inpatient units. Cleveland Clinic Abu Dhabi is the result of an agreement signed in 2006 between Mubadala Investment Company (Mubadala), and US based Cleveland Clinic in support of the Abu Dhabi government’s Economic Vision 2030 to develop a robust, world-class healthcare sector in the Emirate. Licensed by the Department of Health – Abu Dhabi as a research and teaching facility, Cleveland Clinic Abu Dhabi advances clinical care, research, and education, and is the first hospital in the UAE to achieve ACCME® Provisional Accreditation. Internationally recognized,
“Leading a team of 6,000 caregivers, Prof. Haber is a pioneering surgeon renowned for numerous medical firsts, including the first scar-free removal of a healthy kidney for transplant in Europe.
it has been ranked the UAE’s No. 1 research hospital, awarded Magnet® designation, and named Newsweek’s “World’s Best Hospital” in the GCC for four consecutive years.
In July 2025, Cleveland Clinic Abu Dhabi has made history by performing the Gulf region’s first-ever robotic lung transplant making it one of the five centers in the world to have performed this surgery. With this landmark complex surgery, two patients have now successfully undergone robotic lung transplants, marking a major milestone in the region’s advanced surgical and organ transplant capabilities.
These surgeries were quite complex due to pulmonary hypertension, a condition that puts extra strain on the heart and lungs. To support the patients during the operation, the medical team used Veno-Arterial ECMO, a technique that temporarily takes over the work of the heart and lungs while the damaged lungs are replaced.
Also in 2025, Cleveland Clinic Abu Dhabi successfully performed the region’s first liver transplant for colorectal liver metastases, marking a significant advancement in cancer and transplant care in the UAE. Colorectal cancer remains one of the most prevalent cancers in the country, with increasing cases among younger patients. This achievement underscores Cleveland Clinic Abu Dhabi’s dedication to providing innovative solutions for some of the most challenging cancer cases.
As it celebrates a decade of healthcare in 2025, Cleveland Clinic Abu Dhabi continues to align with Abu Dhabi’s Economic Vision 2030 by strengthening the local healthcare ecosystem and delivering exceptional care closer to home. The hospital prioritizes the delivery of compassionate complex care, research for health, and education for those who serve. With the trust of its patients and partners, Cleveland Clinic Abu Dhabi reinforces its leadership in driving innovation and transforming lives across the world.
“The Future of Healthcare in MENA:
Healthcare in MENA: At the Crossroads of Innovation and Necessity Healthcare across the Middle East and North Africa (MENA) is in the midst of an unprecedented transformation. With the sector valued at more than US$135 billion in 2024 and expected to grow at a CAGR of over 10% through 2030, the region is no longer just a consumer of imported healthcare technologies, it is becoming a hub for innovation, investment, and scale.
Fueled by demographic shifts, rising non-communicable diseases, and a youthful population eager to embrace digital solutions, MENA’s healthcare ecosystem stands at the intersection of policy, private investment, and technological disruption. In other words, the future of healthcare here is not just about better hospitals, it’s about rethinking care itself.

“Healthcare in MENA is no longer defined by what’s imported; it’s defined by what’s being built here.


The fundamentals driving healthcare demand in MENA are powerful:
The population is expected to reach 700 million by 2050, with nearly two-thirds under the age of 35. At the same time, lifestyle-related conditions, such as diabetes, cardiovascular disease, and obesity are rising at alarming rates, putting immense pressure on national healthcare systems.
Governments across the GCC and beyond are responding with multi-billion-dollar investments:
> Saudi Arabia’s Vision 2030 allocates significant funding to privatize and digitize healthcare delivery.
> The UAE’s National Strategy for Wellbeing 2031 prioritizes preventive healthcare, telemedicine, and AI adoption.
> Egypt and Morocco are doubling down on universal coverage reforms, creating fertile ground for digital-first startups.
Technology is the common denominator. From AIpowered diagnostics to telemedicine platforms and blockchain-enabled patient records, the region is leapfrogging legacy models of care.

“The pandemic accelerated digital adoption by nearly a decade in healthcare across the region.

While government reforms create the enabling environment, the private sector is where innovation is exploding. In 2024 alone, healthtech startups in MENA attracted more than US$200 million in venture funding, led by platforms in telehealth, mental wellness, and fitness.
> Altibbi (Jordan/UAE): A pioneer in digital consultations, already serving millions across the region.
> Vezeeta (Egypt): Scaling from online booking into telemedicine and digital pharmacies.
> Glucare Health (UAE): Offering both in-clinic and virtual care for diabetic patients, using a remote continuous data-monitoring platform and AI.
> Shezlong (Egypt): Bringing mental health care to mobile screens.
These platforms are not just convenient, they are reshaping access. In rural or underserved areas, telemedicine is bridging gaps that physical infrastructure has never been able to close.
Private hospitals and clinics, too, are investing heavily in digital systems to remain competitive. AI-powered radiology tools, robotic surgeries, and predictive analytics for patient care are becoming less futuristic and more mainstream.
“In MENA, healthtech isn’t just about convenience—it’s about access, affordability, and survival.

One of the most striking shifts in MENA is the consumerization of healthcare. People are no longer passive patients; they are empowered consumers making choices about their health and well-being. This has spurred rapid growth in fitness apps, personalized nutrition, and preventive wellness platforms.
Longevity is emerging as a new frontier. The UAE, in particular, is positioning itself as a hub for
longevity research and regenerative medicine, with Dubai attracting clinics that combine biotech with luxury healthcare experiences. From genomic testing to biohacking retreats, MENA is aligning itself with a global wellness economy worth over US$5 trillion.
The mental health stigma is also being challenged. Platforms like Shezlong, alongside corporate well-being programs, are helping normalize mental wellness as part of overall health, a crucial step in societies where it was once taboo.
“Wellness and longevity are no longer fringe—they are central to the healthcare conversation in MENA.
The Road Ahead: Policy, Investment, and Collaboration
MENA’s healthcare transformation is not without challenges. Regulatory frameworks often lag behind innovation, healthcare spending is uneven across countries, and infrastructure gaps remain. Yet the trajectory is clear: the region is on a fast track to redefine healthcare.
Key success factors going forward include:
> Policy modernization: Clearer regulatory frameworks for telehealth, AI, and data privacy.
> Investment in R&D: Building not just startups, but research capacity to innovate locally.
> Cross-border collaboration: Given the shared challenges such as chronic diseases, young demographics, regional partnerships can unlock scale and efficiency.
As governments, investors, and entrepreneurs converge on this sector, MENA’s healthcare story is shifting from catch-up to leadership. The promise is simple yet profound: to create a healthier, more resilient future for hundreds of millions of people.
“The future of healthcare in MENA will be defined by collaboration between governments, entrepreneurs, and investors.






Source, Lucidity Insights
The Middle East’s healthtech scene is heating up, and a select group of startups are leading the charge in redefining how care is accessed, delivered, and financed across the region. Among the most well-funded ventures are Bayzat, Vezeeta, Altibbi, Okadoc, NewBridge Pharmaceuticals, LVL Wellbeing, and Yodawy. Collectively, these companies reflect the depth and diversity of innovation that is now taking hold across MENA—whether it’s Bayzat digitizing employee benefits and health insurance, Vezeeta building a region-wide digital health marketplace, or Altibbi providing Arabicfirst telehealth solutions. What stands out is the gravitational pull of the UAE: the majority of these scale-ups are headquartered in the Emirates, underscoring the country’s position as the region’s healthtech capital.
In fact, nearly three-quarters of all healthtech venture dollars in MENA are flowing into UAE-based companies, a concentration that influences everything from talent migration and enterprise adoption to where later-stage investors see their strongest opportunities. For entrepreneurs, that clustering creates an ecosystem effect, more accelerators, more regulatory clarity, more access to strategic buyers, which in turn speeds up growth. For investors, it signals a market that’s maturing quickly, with startups not only raising capital but also embedding themselves into national health strategies and payer-provider networks.
At Entrepreneur Middle East, we break down this group into practical profiles that highlight what each company does, where it’s based, and its latest disclosed funding. Different databases may count capital differently, sometimes including convertible notes, venture debt, or undisclosed extensions, but the picture that emerges is clear: this cohort is setting the pace for healthtech in the region. And while a few of these businesses operate with unique models, such as NewBridge Pharmaceuticals’ focus on specialty-pharma commercialization, each one adds to the momentum of a sector that is moving from early experimentation into large-scale adoption. For anyone scouting opportunities, considering partnerships, or analyzing competitors, these startups are the bellwethers for how healthtech in the Middle East is being built today, and how it will shape the patient experience of tomorrow.

What they do:
Bayzat started in benefits brokerage and has evolved into a modern benefits + HR platform for SMEs: plan selection, digitized enrollment, payroll, time & attendance, and healthcare claims/benefits administration—all tied into a single employee experience. In the Middle East context, where health insurance is often employer-mandated, Bayzat sits at the junction of HR ops and healthcare access, making it a gatekeeper for provider networks and wellness programs.
HQ / Country: Dubai, UAE.
Most recent disclosed funding: $25M Series C (Dec 2022), led by DisruptAD (ADQ) and Ischyros; Bayzat states >$60M raised to date across rounds (also echoed by Wamda/Zawya).
Why it matters:
Bayzat’s stack makes it a distribution layer into employer health benefits, with leverage to push e-claims, wellness, and digital navigation at scale. For pharma and diagnostics partners, employers are a route to targeted population programs (e.g., diabetes, maternity), and Bayzat already has the hooks.
Watch-outs:
Benefits broking in the GCC is relationship-heavy; value realization depends on clinical outcomes and measurable cost controls—areas where Bayzat, insurers, and provider networks must align.



What they do:
Yodawy is an e-pharmacy platform that digitizes prescriptions, manages chronic-medication programs, and integrates with payers and employers for at-home delivery. It’s a rails business: the more physicians/e-Rx flows and insurers it supports, the stickier it becomes.
HQ / Country: Cairo, Egypt.
Most recent disclosed funding:
$16M Series B (Feb 2023) led by Delivery Hero Ventures/Global Ventures; additional $10M (Jan 2024) reported by multiple outlets/firm updates. Tracxn shows ~$34.5M cumulative.
Why it matters:
Egypt’s population scale + pharma dynamics make e-pharmacy a high-frequency utility; Yodawy’s B2B2C rails with payers are a moat.
Watch-outs:
Regulatory posture on e-pharmacies differs country-tocountry. Cross-border expansion means playing by local pharmacy and advertising rules.
What they do:
Altibbi is the Arabic-first telehealth and medical content platform: 24/7 remote consultations, content library, and increasingly pharmacy & diagnostics rails—explicitly flagged as Series B expansion priorities. That combination—triage + trustworthy Arabic content + fulfillment—addresses a structural gap in MENA.
HQ / Country:
Jordan-born; now anchored in the UAE.
Most recent disclosed funding: $44M Series B (Mar–Apr 2022) (Foundation
Holdings lead, with Hikma Ventures, Global Ventures, DASH). Total at that time ~$50M.
Why it matters:
Arabic language and regional clinical guidelines are not a “nice to have”—they are adoption prerequisites. Altibbi’s scale and brand give it advantages in payer contracts and government partnerships.
Watch-outs:
Telehealth economics hinge on reimbursement and chronic-care adherence. Moving into pharmacy/ diagnostics introduces compliance and workingcapital complexity, but also deepens ARPU.


What they do:
Okadoc started with instant doctor booking and now positions as a patient-engagement operating layer for providers: real-time scheduling, virtual visits, in-app payments, home care, and a growing cloud pharmacy footprint (especially across KSA and UAE). It sells more B2B than purely consumer.
HQ / Country: Dubai, UAE (regional ops incl. Saudi Arabia).
Most recent disclosed funding:
As a consumer brand with payer and provider integrations, Vezeeta’s breadth (search, book, telehealth, pharmacy) gives it monetization flexibility—advertising, lead gen, transaction margins, subscriptions.
Why it matters:
Okadoc focuses on embedded provider workflows, the boring but sticky stuff (calendars, payments, claims, messaging), which tends to reduce churn vs. pure marketplaces.
Watch-outs:
As more hospitals roll out their own portals/EMR-native tools, Okadoc must keep value ahead via multi-payer integrations and analytics that improve show-up rates, LOS, and collections.
What they do:
NewBridge is a specialty-pharma commercialization platform that brings biologics, therapeutics, and devices into MENA (“AfMET” footprint), handling regulatory, market access, and distribution. It’s not a direct-to-consumer digital product; rather, it’s an enabler for global life-science companies to enter the region.
HQ / Country: Dubai, UAE.
Funding notes:
A $12M Series B first close (2010) brought raisedto-date to $16M, led by Kuwait Life Sciences
Company (KLSC) with Burrill & Co. Multiple trackers repeat that figure; some show later activity, but the publicly cited core round remains 2010.
Why it matters:
In a list dominated by digital platforms, NewBridge represents biopharma enablement—essential infrastructure for novel therapies to reach patients in the region.
Watch-outs:
Because its key financing is older, comparing NewBridge’s “total funding” 1:1 with VC-backed, software-led startups can be misleading; consider commercial revenue and product portfolio as better signals.



What they do:
LVL Well-being sells workplace well-being— mindfulness, coaching, physical health content, live sessions, analytics—targeted to GCC employers. In a benefits-led region, LVL’s platform can plug into HR/benefits ecosystems (including marketplaces like Multiply’s HealthierU).
HQ / Country: Dubai, UAE.
Most recent disclosed funding: $10M Series A (Aug 2023) led by MG Wellness Holding (Multiply Group unit). Confirmed by Lucidity and major UAE media.
Why it matters:
Employers in the GCC are leaning into wellbeing and retention; LVL’s Arabic rollout and content localization are differentiation levers.
Watch-outs:
Proving ROI on well-being is hard. LVL’s success will hinge on measurable outcomes (reduced absenteeism, improved self-reported health) and deep integration into benefits platforms (think Bayzat).


What they do:
Vezeeta built the region’s most recognizable doctor-booking marketplace, expanded into teleconsultations, and added e-pharmacy and postvisit rails. In markets with fragmented outpatient access, Vezeeta’s funnel acquisition and conversion logic (search - book - telemedicine - meds) remains powerful.
HQ / Country:
Founded Cairo (Egypt), now regional footprint.
Funding notes:
Databases generally converge around ~$63–64M total funding; some media cite slightly higher historical totals. (Dealroom/Tracxn show ~$63M; Entrepreneur’s Lucidity-sourced infographic once cited ~$68M.)
Why it matters:
As a consumer brand with payer and provider integrations, Vezeeta’s breadth (search, book, telehealth, pharmacy) gives it monetization flexibility—advertising, lead gen, transaction margins, subscriptions.
Watch-outs:
Booking marketplaces face local challengers and hospital-led scheduling; sustained margins rely on deeper payer/provider integrations and repeat utilization.


Bringing luxury seaside living to Sharjah for the first time, owners at the Anantara Sharjah Residences enjoy access to the Anantara Sharjah Resort’s world-class amenities, including an infinity pool, five distinctive restaurants, an Anantara Spa and a state-of-the-art gym.
As an investment, owners can enjoy the benefits of a rental management scheme operated by Anantara Hotels, Resorts & Spas, allowing them to maximize their returns when they are not resident in the property.
To register your interest, visit arada.com
LIFE IS A JOURNEY.
